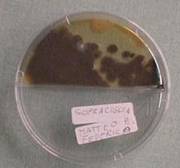

In queste pagine viene presentato un modello di progetto didattico per l'alfabetizzazione scientifica nella scuola elementare, basato sulla sperimentazione.
I percorsi didattici e i materiali sono stati sviluppati nell'ambito del progetto di sperimentazione nell'educazione scientifica "Scienzainrete".
Il percorso proposto prevede un approccio per concetti: a ogni concetto chiave individuato per le diverse classi della scuola elementare viene dedicata un'unità didattica che ne prevede l'esplorazione guidata, l'introduzione, l'applicazione e la costruzione di strumenti di valutazione.
Il progetto didattico proposto è descritto nei dettagli in questa sezione.
Per ogni concetto presentato vengono proposte numerose semplici esperienze da realizzare con i bambini. Il percorso proposto per le diverse classi della scuola elementare è descritto nei dettagli in questa sezione.
Infine, sono riportate diverse descrizioni di esperienze proposte e di esperienze realizzate nelle scuole che hanno aderito al progetto didattico proposto, documentate attraverso disegni, fotografie e video.
La scienza è un patrimonio di procedure e conoscenze condivise. Ma chi affronta terreni vergini in campo scientifico sa bene che il suo operare richiede anche altri ingredienti: atteggiamenti speculativi, esperienza e fiuto, che in genere ci si costruisce da soli, sul campo, sostenuti da predisposizioni e attitudini spiccate che si ritiene riguardino solo una piccola percentuale della popolazione. La sfida consiste nel ritenere possibile allargare la base e insegnare tutti i processi mentali per la risoluzione dei problemi, apprendendo allo stesso tempo i concetti in modo significativo, anche se tutto ciò è ben più difficile che non insegnare e accertare il possesso di contenuti.
Le persone della nostra generazione ricordano la formula per ricavare il volume di una sfera, anche senza aver seguito studi superiori tecnico-scientifici. Tra gli studenti adulti di oggi nessuno (meno dell’1%) conosce tale formula, ma è proprio la mancanza di questa nozione che preclude la capacità degli studenti di determinare il raggio di una sfera di cui è noto il volume? In effetti, semplicemente inserendo le parole raggio, volume e sfera su Google appare la formula nelle poche righe della ricerca, senza neppure aprire le pagine web, e vi si trova perfino la formula inversa. Ma prima di preoccuparsi della formula c’è da verificare il possesso dei concetti di sfera, raggio e volume, quest’ultimo comprendente la certezza di trovare una lunghezza al cubo; poi c’è da accertare la capacità di ricercare, individuare le parole chiave caratteristiche di quell’argomento e la semplice convinzione che debba esistere una relazione unica e ben precisa tra raggio e volume; occorre vedere se tale relazione sia spontaneamente immaginata e ricercata nel tentativo di risolvere un determinato problema e, salendo di livello, quanta fiducia ha lo studente di potersi cimentare con successo in un problema nuovo.
Una formazione scientifica che puntasse solo all’acquisizione di conoscenze, quand’anche “utili” per il futuro cittadino, sarebbe dunque sterile.
Quanto si verifica nella scuola primaria e media determina la possibilità di raggiungere o meno l’obiettivo dell'alfabetizzazione scientifica, intesa come padronanza di atteggiamenti, processi e concetti di base. È inteso che l’alfabetizzazione scientifica non è appannaggio e arricchimento esclusivo degli ambiti tecnologico, scientifico e delle professioni, ma corredo base della globalità dell’individuo.
Ci sono essenzialmente due approcci, ugualmente dignitosi, per la costruzione di tali competenze “scientifiche”:
I due approcci sono abbastanza simili, ma non sempre compatibili. Temi classici sono per esempio la “risorsa acqua”, “l’alimentazione” ecc. All’interno di questi temi possono nascere ricerche, progettazione, laboratori, acquisizione di linguaggi, concetti e atteggiamenti scientifici, cooperazione, specializzazioni in ruoli ecc.
L’approccio b, da noi preferito, si sofferma su un concetto generale alla volta, in una sequenza adeguata allo sviluppo delle capacità dei bambini (concetti di proprietà, sistema, interazione, variabile ecc.) e per ciascuno di questi propone esplorazioni e attività laboratoriali di problem solving che, partendo da diverse angolazioni e con esperienze eterogenee, stimolano l’utilizzo esplicito e in contesto dello stesso concetto generale, fino alla sua incorporazione nel linguaggio spontaneo dei bambini. La nostra preoccupazione, di carattere “propedeutico”, è di costruire gli strumenti necessari per affrontare in futuro le discipline scientifiche e non tanto di fornire “assaggi” o anteprime dei contenuti disciplinari.
Questo tipo di impostazione, ispirata allo SCIS americano degli anni 70-80, ha già dimostrato sul campo (sperimentazione “alfabetizzazione scientifica” del progetto SeT) di produrre validi risultati dal punto di visto cognitivo e affettivo.
Per le unità didattiche si utilizza la metodologia dei cicli di apprendimento di Robert Karplus, principale ideatore dello SCIS. Ogni unità didattica si struttura su un diverso concetto chiave e prevede:
Adottiamo i sei principi educativi generali per l’insegnamento delle scienze nella scuola d’infanzia ed elementare dell’organizzazione francese con partner europei La main a là pâte, validi per qualsiasi progetto di educazione scientifica si voglia avviare.
(Da http://lamap.inrp.fr, corsivi e traduzione nostri)
Il gruppo di Scienza in rete mette a disposizione i propri tutor ed esperti per incontri di formazione, preparazione di segmenti di programmazione e occasionali compresenze in classe a supporto delle esperienze (almeno per le scuole vicine).
A seconda delle richieste e delle necessità, la formazione riguarda:
L’attuazione delle unità e delle esperienze proposte nel percorso seguente non è sufficiente, da sola, a garantire la costituzione di una comunità di sperimentazione didattica.
Perciò agli insegnanti che parteciperanno alla costruzione di percorsi didattici o alla formazione richiediamo l’utilizzo di tecnologie di rete per documentare il percorso e partecipare alla discussione, uscendo dal rapporto limitato tutor-singolo insegnante.
La discussione, che va dal problema di cosa fare il giorno dopo al come utilizzare un manuale scolastico, dovrà essere estesa a tutto il team di insegnanti della scuola e utilizzare il forum riservato alla singola scuola, che sarà appositamente approntato. Tutti gli spunti di discussione interessanti saranno postati anche nel forum generale ad accesso pubblico o dal webmaster, con il consenso del referente, o dallo stesso insegnante. L’utilizzo dell’email dovrà essere limitato alle questioni non riferibili né alla formazione, né alla didattica, né all’organizzazione.
Le ragioni di questa impostazione sono evidenti: per costruire la comunità occorrono interazioni, condivisione e confronto. Questi stessi ingredienti sono necessari per costruire nuove idee e migliorare le pratiche. Infatti, anche se di seguito proponiamo un repertorio di esperienze, dobbiamo avvisare che tale raccolta è stata costruita attraverso interazioni con i bambini e grazie a esperienze dirette in classe e che tale processo di ideazione non solo non si dovrà interrompere, ma dovrà anche assumere un maggior grado di partecipazione e condivisione.
La documentazione del percorso didattico e dei processi attivati prevede:
All’inizio dell’attività occorre inserire una breve presentazione della scuola, che riporti:
Per ogni unità completa (identificata da una parola chiave) si prevedono 6-12 ore fornite nell’ambito scientifico, cioè un arco di 3-6 settimane, comprendendo i tempi per la verbalizzazione e il rinforzo.
In aggiunta il progetto prevede lo svolgimento di attività di vario tipo negli altri ambiti (lettura, individuazione dei termini chiave nelle letture, costruzione di storie, di mappe concettuali, ecc.) correlate alle parole chiave, curando l’estensione e la generalizzazione del significato dei concetti.
Alla pagina dell'Archivio del sito Le parole della scienza si può reperire la documentazione delle esperienze svolte dai componenti il nostro gruppo e da altri insegnanti sull’alfabetizzazione scientifica.
In questa sezione sono trattati i concetti chiave di oggetto – non oggetto, proprietà e materiale.
In continuità con la scuola materna, l’unità sul concetto di oggetto dovrebbe arricchire le competenze nell’uso equilibrato e consapevole dei sensi, a livello percettivo, per compiere osservazioni. Ma anche la sfera logica può essere stimolata, per esempio con operazioni di confronto e con l’uso del non (non-oggetto, non-vivente, non-duro, ecc.). Infine va particolarmente curato l’arricchimento linguistico, anche per preparare un repertorio di termini per il successivo concetto di proprietà. Questo arricchimento “dinamico” comprende la possibilità di coniare nuovi termini o adottare termini dialettali, dotati di maggiore precisione, espressività e significatività per i bambini. Come si vede dall'esempio di percorso che riportiamo, i concetti di proprietà e di oggetto possono anche viaggiare parallelamente e l’analisi sensoriale può essere associata sia alle proprietà sia agli oggetti.
L’unità sul concetto di proprietà ha come prerequisito il concetto di oggetto. Infatti, durante le attività sul concetto di oggetto (svolte soprattutto alla materna) i bambini arricchiscono notevolmente il proprio repertorio linguistico di attributi connotanti gli oggetti: questi non sono altro che le proprietà. Questa unità va coordinata strettamente con l’ambito logico-matematico. Per esempio con i blocchi logici si dovrebbe adottare la stessa terminologia che si utlizza per comparare, classificare e descrivere oggetti naturali: proprietà, spessore, colore, grande-piccolo, pieno-non pieno per i blocchi strutturati, ecc.
Per l'unità sul concetto di materale, la documentazione (compresi numerosi esempi di esperienze) è reperibile a questi link:
1. La scoperta degli oggetti
Da uno scatolone contente oggetti di natura eterogenea estrarre gli oggetti disponendoli in vassoi diversi in base a dei criteri scelti dai bambini (in genere per tipologia). Che cosa si può toccare? Che cosa si può odorare? Che cosa si può sentire dal rumore? Come puoi sentire i tuoi oggetti?
I bambini scelgono un oggetto, lo disegnano sul quaderno e verbalizzano tutto ciò che serve a descriverlo.
La maestra spiega ai bambini che tutte le cose che si possono toccare, odorare e che fanno suoni o rumori, occupano un luogo preciso con dei contorni, sono oggetti. Le cose che non si possono toccare o sentire, non hanno una posizione e dei contorni, sono non oggetti. Esempi di non oggetti sono: il rumore, il silenzio, il buio, l’allegria, la notte, la gioia, la sete, il caldo, il fischio.
Chiede poi di elencare altri oggetti presenti nell’aula. Nello scatolone ci sono cose che non sono oggetti? E nell’aula? Chi conosce oggetti più grandi? E più piccoli? E i più lontani? Fuori dall’aula? I bambini sono oggetti? Mettiamo i bambini in ordine di altezza crescente. Tutti gli oggetti hanno un nome?
2. Gioco della scatola misteriosa
Alcuni bambini scelgono un oggetto (da un insieme di oggetti facilmente riconoscibili: gomme, matite, pezzi di pongo, palline di vetro o gomma, ruote giocattolo, automobiline o altri giochi ecc.) e lo mettono in una scatola dove si può infilare solo una mano. Gli altri devono riconoscerlo dal rumore e dalle sensazioni tattili.
3. Quale oggetto è più…
... grande/piccolo, spesso/sottile, liscio/ruvido, duro/morbido, leggero/pesante, freddo/caldo, umido/asciutto, ecc. Nella scatola misteriosa stavolta ci sono tre oggetti, tra cui occorre scegliere quello che ha una qualità più spiccata degli altri usando solo il tatto.
4. Distinguiamo gli oggetti dal rumore
5. Distinguiamo gli oggetti dall’odore
Utilizzare frutta, erbe aromatizzanti, spezie, ecc.
6. Quale collana è più lunga, quale più corta, quale contiene più palline e quale di meno?
In questo gioco i bambini hanno a disposizione la pastina a tubetti o anellini o perline colorate di vari tipi. Realizzano collanine e, a gruppi di quattro, senza intervento da parte dell'insegnante, confrontano le collanine. L'obiettivo è confrontare gli oggetti in base al numero e alla lunghezza e distinguere tra i due criteri (che sono anche proprietà delle collanine).
7. Quali sono non-oggetti? (Attenzione: questa esperienza comporta che i bambini sappiano leggere in stampatello)
Ogni gruppo di bambini riceve dei cartoncini con scritti dei nomi. Si devono riconoscere quali sono oggetti e quali non lo sono. Esempi di oggetti: ago, chiodo, uovo, mela, trottola, cane, fuoco, casa, chiesa, luna. Esempi di non-oggetti: sogno, cielo, notte, giorno, numero, salto, gioia, silenzio, sforzo, tempo, amicizia.
Tutti gli oggetti hanno un nome. Ogni nome corrisponde a un oggetto? I bambini a casa ritaglieranno da un giornale le parole che indicano oggetti e quelle che indicano non-oggetti e li incolleranno in due diverse pagine di quaderno preparate a scuola.
8. Oggetti viventi/non-viventi
Questa complessa attività deve basarsi su immagini e oggetti concreti, come piume, pigne, conchiglie, uova, foglie e pezzi di legno, sull’esperienza con semi e viventi osservati in classe o all’aria aperta nel loro agire e trasformarsi, e non solo sui nomi dei viventi.
Deve inoltre essere condotta partendo dal dialogo e dai concetti dei bambini, che dovranno essere guidati alla negoziazione e condivisione di criteri di classificazione. È possibile, anzi quasi certo, che emergano classificazioni non dicotomiche e difformi da quelle adottate dalla biologia (caratterizzate da definizioni e criteri al massimo grado di generalizzazione e applicabilità). Per esempio i bambini possono definire il vivente come integro, esistente, vivo, funzionante, capace di una qualsiasi attività (usando, ovviamente, altri termini).
L’insegnante curerà soprattutto che i criteri siano specificati, confrontati tra bambini e usati coerentemente. Quindi la sua funzione sarà di attirare l’attenzione su certe costanti nei modi di essere e di agire dei viventi che i bambini sottovalutano e di ampliare, assemblandole tra loro, le definizioni dei bambini per renderle un po’ più generali, ma senza la pretesa di arrivare alla definizione biologica.
Inoltre può essere necessario e importante che la maestra aiuti i bambini a distinguere il reale dal fantastico degli oggetti “antropomorfizzati” (libri e alberi parlanti, ecc.).
Non importa se rimarrà qualche oggetto naturale chiaramente non-vivente che rientrerà nella definizione di vivente così costruita, purché non siano gli stessi bambini a rilevare il problema. In altre parole esisterà la definizione di vivente della data classe, e non “la” definizione.
1. Raggruppa gli oggetti a tua disposizione
A ciascun bambino si consegna un vassoio con una serie di 6-10 oggetti dello stesso tipo (conchiglie, sassi, piume, semi, bottoni, palline di vetro, ecc.). I diversi bambini possono esplorare oggetti di diverso tipo. Durante lo svolgimento della consegna, è fondamentale rivolgere la domanda: “perché hai messo insieme questi oggetti?” L’insegnante può anche registrare sulla lavagna i diversi criteri di classificazione usati, in uno schema come il seguente:
|
Nome |
Tipo di oggetti raggruppati |
Stanno insieme perché sono tutti… |
|
Gianni |
Conchiglie |
A punta/rotonde |
|
Luca |
Tappi |
Di sughero/colorati |
|
Renato |
Conchiglie |
Grandi/piccole |
|
Marta |
Semi |
Bianchi/rotondi/marroni/fini |
|
Ecc… |
Ecc… |
Ecc… |
Per l’insegnante: la tabella evidenzia la distinzione tra tipologia (ci dice che cos’è) e proprietà (ci dice come è). Quindi è da escludere che la tipologia di oggetti possa essere considerata una proprietà degli oggetti. Da un insieme eterogeneo di oggetti possiamo isolare tutti i bottoni, ma essi non hanno la “proprietà” di essere bottoni. Per quanto riguarda la specificazione del tipo di materiale, essa può essere considerata come proprietà, poiché in questo contesto è utilizzata come attributo (di ferro, di plastica, ecc.)
La maestra riprende tutte le spiegazioni dei bambini e afferma che l’essere grande, piccolo, marrone, bianco, rotondo o fine, sono tutte proprietà degli oggetti, ci dicono qualcosa su come sono gli oggetti. Prendendo due oggetti diversi in mano, spiega che, anche se i due oggetti sono differenti, hanno alcune proprietà in comune, che passa ad elencare. Chiede poi ai bambini di dire quali proprietà ha un qualsiasi oggetto dell’aula. Infine i bambini possono raccontare le proprietà di oggetti della loro esperienza quotidiana, ma assenti al momento, specificando anche quali si riconoscono con la vista, quali con l’odorato o il gusto, quali con l’udito, quali con il tatto.
2. Per quale colore ci sono più caramelle?
Utilizzare un piattino di carta con una dozzina di “smarties” per ogni gruppetto di bambini e una coppa o piattino trasparente. Ogni gruppo, alzando il proprio piattino trasparente con le caramelle del colore più abbondante, lo mostrerà agli altri che lo vedranno da sotto e le caramelle dello stesso colore saranno contate. La maestra scriverà alla lavagna le due proprietà numero e colore su due colonne.
| Proprietà | |
| Colore | Numero |
| Giallo | 5 |
| Rosso | 6 |
| ... | ... |
Le caramelle possono essere distribuite in modo che ogni gruppo abbia un colore prevalente diverso. Si chiede anche quanti diversi colori ci sono.
I bambini chiederanno di poter mangiare le caramelle. Si risponderà loro che sono sporche, e che potranno mangiare quelle ancora nei tubetti, se indicheranno quali altre proprietà si “sentono” mangiandole. I bambini scopriranno che le caramelle di colori diversi hanno altre proprietà (sapore, odore, consistenza dura-morbida) identiche.
3. Puoi riconoscere gli oggetti ad occhi bendati e senza toccarli?
I bambini riconosceranno gli oggetti utilizzando l’udito e l’olfatto, mentre i loro compagni faranno cadere gli oggetti sul banco o li porranno vicino al naso. Si evidenzieranno quindi altre proprietà, come il rumore prodotto cadendo e l’odore. L’esperienza può essere effettuata una volta per il rumore e un’altra volta per l’odore.
Per la proprietà rumore si possono usare oggetti solidi (chiodi, biglie di vetro, gomme, legnetti, pezzi di plastica, palline di carta, ecc.) o liquidi (acqua, olio e bicchieri vuoti per il travaso).
Per la proprietà odore si possono utilizzare arance, limoni, cipolle, foglie aromatizzanti (rosmarino, menta, basilico, salvia, ecc.) o liquidi (aceto, olio d’oliva, latte, vino, Coca Cola, aranciata, limonata).
Si può evitare di coprire gli occhi con le bende, lasciando in infusione in acqua le foglie aromatiche o le bucce dei frutti e usando (entro breve tempo dall’estrazione dei solidi) il liquido limpido per l’esperimento di riconoscimento dell’aroma. In questo caso i bambini potranno letteralmente “fiutare le proprietà” che gli oggetti hanno trasferito all’acqua.
Un analogo esperimento può essere realizzato riconoscendo vari sapori (sono anch’essi proprietà) - come dolce, salato, aspro, amaro - ottenuti per esempio mettendo in acqua dello zucchero, del sale, del succo di limone o del bicarbonato.
Attenzione: Le due seguenti esperienze hanno l’obiettivo di discriminare la forma dalla dimensione e vanno effettuate necessariamente in successione.
4. Grandi, piccoli e piccini
I bambini a coppie ricevono un vassoio con oggetti di un solo tipo, caratterizzato da diverse forme (non necessariamente regolari) e dimensioni (per esempio bottoni, pastine, conchiglie, foglie), con la consegna di raggruppare tali oggetti in base alle dimensioni.
5. Quante forme ci sono?
I bambini a coppie ricevono un vassoio con oggetti di una sola tipologia (diversa dalla precedente), aventi una varietà di forme e dimensioni (per esempio bottoni, pastine, conchiglie, foglie), che dovranno raggruppare in base alla sola forma. Una volta fatto, ai bambini si chiederà di dare dei nomi alle forme (per esempio allungata, corta, piatta, sottile, scavata, forata, rotonda, appuntita, ecc.)
Attenzione: Le esperienze 4 e 5 possono essere ripetute utilizzando insiemi eterogenei di oggetti di tipo diverso. In questo caso lo stesso insieme di oggetti viene raggruppato sia per forma che per dimensione.
6. Scegli le proprietà del palloncino preferito
Da un insieme di molti palloncini colorati di diverse forme e lunghezze, i bambini potranno scegliere e impossessarsi, a turno, di un palloncino di gomma, se ne indicheranno tutte le proprietà (colore, forma e dimensione; per esempio: grande, rotondo, verde). Dal punto di vista logico i bambini devono utilizzare più criteri di classificazione contemporaneamente (inclusivo, intersezione) e questo compito sarà agevolato una volta che avranno imparato a discriminare i concetti di dimensione e forma. Sono molto importanti i collegamenti con l’attività di matematica e italiano.
7. Raggruppiamo le proprietà
La maestra distribuisce a tutti i bambini foglietti con diversi attributi facenti capo alle proprietà colore, forma, dimensione, sapore, odore, rumore, tatto, numero o quantità, includendo i più comuni e soprattutto quelli che sono stati messi in gioco nelle attività precedenti. Quindi chiede ai bambini: “chi ha un cartoncino che ci dice qualcosa sulla proprietà… colore (o forma, o dimensione, ecc.)?” Oppure potrà chiedere: “chi ha un cartoncino con una proprietà che si può sentire con il naso (o con l’olfatto, ecc.)?”
Una variante di questa importante attività di sistematizzazione delle proprietà è quella di avere oggetti sul tavolo corrispondenti alle proprietà dei cartoncini, che i bambini potranno indicare.
Durante l’attività si realizza uno schema di tutte le proprietà, con relativi esempi. Tale schema si può costruire un po’ per volta sulla parete dell’aula con foglietti mobili.
8. C’è una proprietà che è uguale per tutti gli oggetti del vassoio?
Nel vassoio si mettono 2-4 oggetti di tipo completamente diverso tra loro, ma che abbiano almeno una proprietà comune (colore, forma, sapore, lunghezza, morbidezza, numero di parti, materiale, ecc.); per esempio, quattro bottoni di forma, dimensioni e colore diversi, ma tutti con quattro buchi. I bambini dovranno identificare una proprietà comune. Ogni gruppo mostrerà agli altri i propri oggetti spiegando qual è la proprietà comune tra loro.
La maestra potrà chiedere poi: quali proprietà sono comuni a Gianni e a Lucia? Sono uguali Gianni e Lucia? Sono completamente diversi, cioè diversi in tutte le proprietà? Si possono poi organizzare dei giochi in cui la maestra raggruppa i bambini per una o più “proprietà” comuni e chiede al resto della classe di stabilire quali sono le proprietà dei bambini dell’insieme (per esempio: capelli lunghi o corti, con fermacapelli o senza, bambine con la gonna, ecc.). Una volta che i bambini avranno apprezzato il gioco potranno anche invertire le parti e chiedere alla maestra di indovinare la proprietà con cui si sono raggruppati.
9. Quanti tipi di frutta secca ci sono?
Ogni bambino deve trovare un modo per riconoscere la sua arachide e darle un nome. I bambini separeranno noci, mandorle, nocciole e arachidi in pochi secondi. Poi la maestra chiederà se gli oggetti di ciascun gruppo sono identici. Quando sarà chiaro che ci sono piccole differenze in alcune proprietà, si lasceranno ai gruppi (di 4 bambini) solo 4 arachidi e si procederà alla differenziazione di queste, la parte più interessante del problema. È un’esperienza per distinguere il concetto di identico da quello di simile e per affinare le capacità di osservazione. Ogni gruppo di bambini avrà una lente a disposizione, con cui osservare, a turno, la propria arachide fino a trovare degli elementi distintivi che gli consentono di identificarla tra le quattro. La maestra verificherà se i bambini sono in grado di riconoscere le proprie arachidi chiedendo loro, prima di mescolarle, i nomi e con quali particolari proprietà sono in grado di riconoscerle. Come applicazione di questa attività i bambini, con la loro lente, potranno in seguito discriminare piccoli dettagli di conchiglie della stessa specie e dimensione o portare da casa oggetti che secondo loro sono perfettamente identici.
10. Nel bicchiere ci sono semi diversi: separa, conta e identifica i semi. Quali sono le loro proprietà?
Si trovano in commercio sacchetti di legumi misti di molti tipi e colori, che sono l’ideale per quest’esperienza. L’obiettivo è di mostrare come l’identità di un oggetto può essere stabilita solo in base a un insieme di proprietà, ma anche evidenziare la differenza tra identità e proprietà (non può essere considerata una proprietà la natura di seme o di foglia o l’essere un tappo o una biglia), notando che tutti i semi dello stesso tipo, pur avendo comunanza di proprietà, non sono perfettamente identici.
11. Metti in ordine per una proprietà le foglie raccolte nella passeggiata
L'attività consiste nel creare serie di foglie secondo la lunghezza, l’intensità del verde, la grandezza, il numero di foglioline nelle composite o di lobi nelle palmate.
Si possono risolvere altri problemi sperimentali sull’ordinamento qualitativo delle proprietà, che prepara al concetto di variabile.
Il percorso di Gisella, maestra della classe I della Scuola Elementare di Appignano (MC), realizzato nell'anno scolastico 2003/04.
1. L’insegnante invita i bambini a portare a scuola alcune cose in un sacchetto trasparente. I bambini portano bottoni, ceci, fagioli, giocattolini, tappi, sassi, pinoli, figure, ecc. Da uno scatolone, dove sono stati sistemati gli oggetti, l’insegnante ne prende alcuni per volta invitando gli alunni a dire come sono.
2. Osserviamo con la vista e scopriamo i colori, le forme, le dimensioni; per esempio: forme delle foglie (cuoriforme, palmata, lanceolata, aghiforme, ovale), colore e dimensione.
3. Osserviamo con il tatto, attraverso il gioco della scatola misteriosa (vedi Esperienze sul concetto di oggetto - non oggetto, esperienza 2): infilando la mano nella scatola scoprire l’oggetto nascosto e dire le sue proprietà in base alle sensazioni tattili.
4. Osserviamo gli oggetti dal rumore e soprattutto stabiliamo la provenienza dei suoni, elencando tutti i suoni che si sentono fuori dall’aula e in casa.
5. Osserviamo gli oggetti dall’odore, attraverso il gioco della scatola misteriosa (vedi Esperienze sul concetto di oggetto - non oggetto, esperienza 2): ipotizzare l’oggetto nascosto annusandolo.
6. Osserviamo gli oggetti attraverso il sapore: si mettono delle polveri bianche e inodori in due barattoli. La vista, l’olfatto e l’udito danno sensazioni analoghe, mentre il gusto fornisce una differenza (dolce – salato).
7. Chi ce lo dice? Esperienza di associazione delle proprietà ai sensi: la scheda contiene al centro un’icona per ogni senso, disegnata dai bambini, e alcuni termini (per esempio: è colorato, è luminoso, è puzzolente, è caldo, è liscio, è rotondo, è dolce, è amaro, è salato, è rumoroso, è morbido, ecc.) in riquadri da collegare ai rispettivi sensi.
Ogni oggetto ha delle proprietà, cioè delle caratteristiche che puoi percepire usando i cinque sensi.
Classificare oggetti
1. Classificare oggetti per tipologia: dall’insieme contenente tappi e bottoni dividere in due insiemi, di tappi e di bottoni.
2. Classificare oggetti di un solo tipo (per esempio bottoni) sulla base delle differenze in una singola proprietà, per esempio il colore (trasparente, grigio, marrone, bianco, celeste, scuro, ecc.), la grandezza (piccoli, medi, grandi), il numero di buchi (zero, uno, due, quattro), il materiale (plastica e metallo, solo plastica, solo metallo) e così via.
Dagli oggetti alle proprietà
1. Elencare le proprietà possedute da un oggetto (cannuccia, biscotto, ecc.).
2. Descrivere le proprietà tattili di un oggetto nella scatola misteriosa (sasso, spugna, ecc.)
3. Descrivere un oggetto in base a proprietà indicate in tabella (forma, colore, dimensione)
4. Dati due oggetti trovare le proprietà che hanno in comune (vedi Esperienze sul concetto di proprietà, esperienza 8)
Dalle proprietà agli oggetti
1. Riconoscere gli oggetti dall’odore (caffè, rosmarino, mandarino, lavanda, aceto, saponetta, alcol, ecc.).
2. Disegnare un oggetto qualsiasi che ha la proprietà indicata: "duro come…", "liscio come…", "friabile come…", "luminoso come…", ecc.
3. Scegliere tra gli oggetti quello che ha una certa proprietà (liscio, ruvido, pesante, leggero, duro, morbido, caldo, freddo, ecc.).
4. Riconoscere l’oggetto che ha tutte le proprietà indicate (classificare).
5. Applicazioni allo studio dell’ambiente “prato”, adiacente alla scuola:
In questa sezione sono trattati i concetti chiave di materiale, interazione e sistema.
Il concetto di materiale, cioè quello di cui sono fatti gli oggetti, viene introdotto attraverso esercizi di raggruppamento degli oggetti e descrizione delle loro proprietà.
Il possesso del concetto di interazione è in linea con lo sviluppo di una mentalità scientifica, poiché il descrivere cambiamenti in termini di evidenze, riproducibilità, causa-effetto è una delle principali attitudini scientifiche, che in aggiunta possono essere utili anche nell’analisi di altri ambiti.
Gli obiettivi sono:
L'unità didattica dedicata al concetto di sistema ha i seguenti obiettivi:
1. Di che cosa sono fatti questi oggetti? Formare gruppi di oggetti fatti dello stesso materiale.
I bambini ricevono un vassoio con una decina di oggetti formati da tanti materiali quanti sono i gruppi di bambini, scegliendo tra: vetro, legno, stoffa, gomma, gesso, plastica, metallo, carta, cera, legno, polistirolo, sughero, pietra ecc. Quindi raggruppano tali oggetti per materiali. La maestra chiede poi a ciascun gruppo di che cosa sono fatti gli oggetti raggruppati e raccoglie gli oggetti da tutti i gruppi per ciascun materiale, disponendoli in ordine al centro della classe. I bambini scrivono su dei cartoncini i nomi dei materiali da mettere davanti a ciascun gruppo di oggetti. Gli oggetti raggruppati per materiali saranno usati per il successivo esperimento 4 sul galleggiamento.
2. Il materiale dice di che cosa è fatto un oggetto
Si domanda ai bambini: quali materiali conoscete oltre quelli che avete qui davanti? Di che materiale è fatto il tavolo? Il tronco dell’albero? ecc.
3. I materiali si riconoscono per le loro proprietà
Quali sono le proprietà del legno? del vetro? ecc. Esistono materiali liquidi?
4. Quali materiali galleggiano nell’acqua?
Il test di galleggiamento, per ogni oggetto, va effettuato con un grande barattolo di vetro, immergendo gli oggetti al centro per poi lasciarli liberi di affondare o risalire a galla. Esistono materiali plastici che affondano ( PET, PVC, PS) e altri che galleggiano (PE, PP).
5. La solubilità è la proprietà di sciogliersi. Quali materiali presentano solubilità in acqua?
Provare con sale, zucchero, gessetto tritato, caffè, olio, aceto. Costruire tabelle delle diverse proprietà di questi sei materiali. Una materiale è solubile quando il liquido ottenuto rimane trasparente (soluzione). Il latte è una non soluzione perché non consente di leggere una scritta posta sotto la base del bicchiere di vetro che lo contiene. Anche mescolando acqua e olio si ottiene per qualche secondo un liquido non trasparente. I bambini potranno usare il test di trasparenza per riconoscere se c’è stata solubilità o se il solido si è semplicemente disperso nel liquido.
6. Quanti materiali metallici puoi trovare? Quali sono magnetici?
I bambini descrivono alcune proprietà che differenziano diversi metalli e quelle caratteristiche di tutti i metalli. Utilizzare oggetti di ferro, rame, piombo, alluminio, ottone, bronzo, argento, anche monete, ma non quelle da 1, 2 e 5 centesimi, che sono d’acciaio rivestito di rame e sono magnetiche pur sembrando di rame.
1. Quante e quali azioni può fare un oggetto o un materiale sull’altro?
Il vassoio di ciascun gruppo contiene: lana di ferro sottile, magnete, guscio d’uovo o pezzetto di marmo, succo di mirtillo o infuso di radicchio filtrato preparato in giornata, aceto, bicarbonato. Si possono unire materiali e oggetti solo a coppie.
Non è tanto importante che l’interazione sia realmente presente (possono esserci casi dubbi), quanto l’atteggiamento da parte dei bambini di portare prove che tale azione reciproca sia avvenuta.
È anche importate trovare esempi di non-interazione, cioè situazioni in cui i bambini stessi, non riscontrando evidenze (a loro giudizio), sostengono che non c’è cambiamento rilevante.
I bambini osservano accuratamente e scrivono i cambiamenti che si producono in entrambi i materiali o negli oggetti uniti. L’insegnante spiega che in tutti i casi c’è stata un’azione tra l’uno e l’altro oggetto o materiale, scrive la parola interazione, cioè “azione tra oggetti o materiali” per designare tutti questi casi.
L’insegnante fa altri esempi (con gesso/lavagna, matita/temperino, carta/matita, forbici/carta, termosifone/aria ecc.) chiedendo ogni volta se c’è interazione e perché (in base a quali cambiamenti nell’uno e nell’altro oggetto) e chiama evidenze dell’interazione questi cambiamenti. I bambini potranno anche parlare a casa di questa nuova “parola” e cercare altri esempi di interazione, scrivendoli sul quaderno.
2A. Riesci a far interagire la pila e la lampadina?
Da fare con pila da 4,5 V piatta e lampadina per albero di Natale esterno da 14 V.
2B. Riesci a far accendere la lampadina?
La maestra consegna una batteria, un filo e una lampadina (da fare con pila stilo o mezza torcia, lampadina piccola da 2,2 V e filo da 12 cm scoperto alle estremità).
3. C’è interazione tra BTB blu e aceto? Quali sono le evidenze dell’interazione?
4. C'è interazione fra la compressa e il BTB blu? Quali sono le evidenze dell’interazione?
5A. C'è interazione tra il respiro e il BTB blu? Quali sono le evidenze dell’interazione?
5B. Hai a disposizione una pompa per bicicletta e un bicchiere con BTB blu. C’è interazione tra l’aria e il BTB?
In questo caso non si avrà alcun cambiamento di colore. Si può chiedere se l’aria espirata ha qualche proprietà diversa da quella che entra nella pompa. I bambini possono capire che l’aria della pompa è la stessa che essi inspirano, ma che non è più la stessa quando la espirano, trasformata, attraverso la cannuccia e nel BTB. Un passo ulteriore è chiedere: dov’è avvenuto il cambiamento dell’aria? Cosa c’è stato tra aria “normale” e polmoni (o corpo umano)?
6. Quale barattolino contiene un pezzo di ferro?
A disposizione ci sono 4 barattolini porta-pellicole neri contenenti piccolissimi oggetti di metallo non magnetico, di cui solo uno è un chiodino da suole. Si può usare una calamita ma non aprire i barattoli. Il magnete e l’oggetto metallico devono essere scelti in modo che il secondo resti attratto dal magnete rimanendo sotto al tappo, mentre deve risultare impossibile sollevare tutto il barattolo con l’oggetto ferroso.
Le esperienze sull’interazione possono essere considerate come altrettante attività di esplorazione del concetto di sistema, pertanto si può partire direttamente dall’introduzione del nuovo concetto.
Le esperienze sull’interazione già svolte possono essere rievocate dalla maestra, anche mostrando gli oggetti già usati, per evidenziare che esiste sempre un gruppo di oggetti legati, insieme con altri oggetti che invece non prendono parte o non hanno relazioni importanti con i primi.
La maestra spiega che ogni volta che se degli oggetti possono interagire tra loro, essi formano un sistema. La pila il filo e la lampadina formano un sistema perché tali oggetti possono interagire o sono legati in modo tale da interagire.
Quindi richiede ai bambini di fare altri esempi, chiedendo al proponente quali oggetti o parti compongono il sistema proposto e agli altri bambini di dire se concordano con gli oggetti elencati o se pensano di includerne/escluderne qualcuno. Ogni insieme proposto dovrebbe essere denominato (per esempio: sistema fiamma, sistema elettrico, ecc.) e rappresentato, in fase di verbalizzazione, con una semplice mappa concettuale in cui le connessioni rappresentano elementari relazioni di appartenenza o funzione e i collegamenti trasversali indicano le interazioni tra gli elementi del sistema. L’associazione ambiente-organismo può essere considerata un sistema, così come l’alveare.
1. Come si fa a far interagire una candela accesa e il BTB blu posto sul fondo di un barattolo?
I bambini possono fare varie ipotesi che devono essere descritte come altrettanti sistemi diversi.
Il BTB cambierà colore solo se la candela brucerà nel barattolo chiuso. Si distinguono sistemi aperti e sistemi chiusi. Solo i primi permettono l’entrata e l’uscita di materiali, mentre i sistemi chiusi possono scambiare solo energia con il loro intorno. Si possono perciò far proporre altri esempi di sistemi aperti e di sistemi chiusi anche senza parlare di energia.
2. Eseguire un esperimento in cui il sistema "aceto-bicarbonato" è chiuso
A disposizione ci sono un sacchetto di plastica, un bicchiere con aceto e un cucchiaio di bicarbonato.
Due bambini possono mostrare alla classe come il bicarbonato interagisce con l’aceto in un bicchiere trasparente. Si descrive questo tipo di sistema aperto. Quindi i gruppi affrontano il problema di fare la stessa cosa in un sistema perfettamente chiuso. Una soluzione consiste nel mettere il bicarbonato nel sacchetto con mezzo bicchierino da caffè contenente aceto forte, e nel far interagire i due materiali solo quando il sacchetto sia stato ben sigillato con un laccio. In tal caso il sacchetto si gonfierà e diventerà duro.
3. L'insegnante consegna cinque cartoncini col nome di un animale e cinque cartoncini col nome di un ambiente. In quale ambiente vive ciascun animale?
4. Il sistema “prugna secca” (o il sistema fagiolo) è aperto o chiuso quando viene messo in acqua?
La prugna secca (se non snocciolata) dopo qualche ora in acqua si rigonfierà fino ad assumere la dimensione originaria. Nonostante la somiglianza con l’esperimento del sacchetto che si gonfia, questo sistema è aperto; il calo del livello dell’acqua esterna dimostrerà che tale materiale è entrato nel sistema. L’insieme "bicchiere, acqua e prugna" è invece un sistema chiuso.
5. Con acqua e farina formare un sistema “non-soluzione” e poi separare di nuovo l’acqua dalla farina bagnata.
6. Con acqua e sale formare un sistema “soluzione” e poi separare di nuovo il sale.
7. Con una bottiglia, un palloncino, aceto e bicarbonato, fare un sistema chiuso che fa gonfiare il palloncino. Il sistema è aperto o chiuso?
In questa sezione sono trattati i concetti chiave di interazione, sistema, sottosistema, variabile.
La classe terza effettuerà un sufficiente numero di esperienze sul concetto di interazione e sul concetto di sistema, descritte per la classe seconda, in modo da aver tempo per sviluppare anche i concetti di sottosistema e variabile.
L'unità sul sottosistema non aggiunge contenuti nuovi. Quando un sistema è parte di un altro, come la corolla, o il fiore o l’albero, è chiamato sottosistema. Ogni sistema complesso, dal corpo umano al bosco, contiene tanti sottosistemi aventi relazioni funzionali tra essi e tali che l’insieme è qualcosa in più della somma delle singole parti. L’interesse dell’osservatore determina, volta per volta, la scelta di cosa considerare sistema, sottosistema e oggetto.
Gli obiettivi di questa unità sono:
Il concetto di variabile è fondamentale per preparare una solida base alla comprensione e alla pratica delle scienze.
Così come un sistema può essere analizzato nei suoi sottosistemi e nelle relazioni che li legano, una spiegazione di un fenomeno complesso si basa sull’analisi e registrazione delle variabili. Le variabili sono proprietà che si modificano o nel tempo (per esempio l'altezza di un bambino negli anni) o nello spazio (per esempio l'altezza dei diversi bambini della classe). Possono essere misurabili quantitativamente (per esempio l’altezza) o non esserlo (per esempio la forma dei solidi o il colore dei capelli). Possono essere “aleatorie” (per esempio il numero di uscute testa in dieci lanci) o “deterministiche”, cioè riproducibili (per esempio l'ampiezza di un’oscillazione) e con andamento regolare (per esempio la crescita di un capello).
Se in un fenomeno o in un sistema ci sono più variabili, queste possono essere indipendenti (per esempio il colore delle auto e la probabilità di subire incidenti) o correlate (per esempio il peso delle automobili e il consumo in km/litro), e può esserci o meno un rapporto asimmetrico di causa-effetto che le lega tra loro (il consumo delle auto è dipendente dalla variabile peso e non viceversa; invece le variabili diametro e circonferenza dei cerchi sono perfettamente dipendenti l’una dall’altra, senza che si possa stabilire una causa e una conseguenza). Dal punto di vista della progettazione di esperimenti equi e imparziali è fondamentale stabilire le variabili indipendenti che devono essere mantenute costanti e quelle che si debbono cambiare sistematicamente. Atteggiamento utile anche a chi farà il giornalista, il politico o si occuperà di marketing.
Da questa rapida elencazione di casi si capisce la complessità ma anche l’utilità di tale concetto.
Il concetto di variabile è un grande contenitore di concetti, come quelli di misura e di unità di misura, correlazione, rapporto, probabilità, e di strumenti grafici come diagramma cartesiano, istogramma, ecc. Anche se viene introdotto dalla terza elementare, tale concetto sarà ripreso e approfondito in tutti gli anni che seguiranno.
Rispetto agli altri ambiti c’è solo l’imbarazzo della scelta per trovare esempi di variabili.
|
Ambito |
Variabili |
|
Antropologico |
Estensione territoriale, disponibilità alimentari, distribuzione delle ricchezze, risorse, tipo di organizzazione sociale e di governo ecc. ecc. |
|
Linguistico |
Variabili grammaticali come tempo e persona dei verbi; variabili del testo come espressività nel tono di lettura, codici del testo scritto ecc. |
|
Motorio |
Tempo, ritmo, sequenza, posizione di partenza e arrivo, velocità, estensione, forza, peso, altezza |
|
Logico-matematico |
Geometriche: numero lati o angoli, lunghezza, area, volume. Aritmetiche: numeri (il risultato di un’operazione è una variabile dipendente dagli operandi), popolazione di un insieme. Logiche: corrispondenza (univoca o biunivoca), verità (vero o falso), ecc. |
Gli obiettivi per questa unità per la terza elementare sono:
Si possono inserire le seguenti variazioni alle esperienze 1 e 2 di applicazione del concetto di sistema descritte per la classe seconda ed effettuare le nuove esperienze 3 e 4, di seguito descritte e più adatte ai bambini di terza.
1. Come si fa a far interagire una candela accesa e il BTB blu posto sul fondo di un barattolo?
I bambini possono fare varie ipotesi che devono essere descritte come altrettanti sistemi diversi.
Il BTB cambierà colore solo se la candela brucerà nel barattolo chiuso. Si distinguono sistemi aperti e sistemi chiusi. Solo i primi permettono l’entrata e l’uscita di materiali. (I sistemi chiusi possono scambiare solo energia con il loro intorno). Si possono perciò dire altri esempi di sistemi aperti e di sistemi chiusi anche senza parlare di energia. In terza classe si può chiedere di fare ipotesi su quale sia la causa del cambiamento di colore. Tali ipotesi possono essere verificate. Individuata l’ipotesi confermata (diranno: il fumo o l’aria consumata dalla candela ecc., confermabile mettendo un bicchiere con poco BTB blu nel barattolo anche parecchio tempo dopo lo spegnimento della fiamma) i bambini potranno collegare questo fenomeno agli altri riguardanti la respirazione, cogliendone l’elemento comune.
2. Eseguire un esperimento in cui il sistema "aceto-bicarbonato" è chiuso
A disposizione ci sono un sacchetto di plastica, un bicchiere con aceto e un cucchiaio di bicarbonato. Due bambini possono mostrare alla classe come il bicarbonato interagisce con l’aceto in un bicchiere trasparente. Si descrive questo tipo di sistema aperto. Quindi i gruppi affrontano il problema di fare la stessa cosa in un sistema perfettamente chiuso. Una soluzione consiste nel mettere il bicarbonato nel sacchetto con mezzo bicchierino da caffè contenente aceto forte, e nel far interagire i due materiali solo quando il sacchetto sia stato ben sigillato con un laccio. In tal caso il sacchetto si gonfierà e diventerà duro.
Anche in questo caso, in classe terza, si potranno fare ipotesi sulla natura e sulle proprietà del “tipo di aria” che ha riempito il sacchetto. Sarà la stessa che risulta dall’interazione con i polmoni e prodotta dalla combustione della candela? Questa ipotesi può essere verificata infilando una cannuccia nell’apertura del sacchetto, stringendolo e facendo gorgogliare il gas in un bicchiere con del BTB blu, che virerà al giallo.
3. Con una pila da torcia, due fili e una mina per matita, costruire un sistema “scaldabagno”, capace di scaldare l’acqua.
Il circuito va montato come nell’analogo esperimento con la pila il filo e la lampadina, ma in questo caso l’uso di due fili semplifica l’operazione. I due fili sono attorcigliati alle estremità della mina, immersa in acqua. Quando è tutto pronto si collegano le estremità libere dei fili ai due poli della batteria e la mina diventerà calda. Occorre una batteria da torcia da 1,5 V delle più grandi o una piatta da 4,5 V, per avere un’erogazione abbastanza prolungata di calore e una mina da disegno. In tal caso l’innalzamento di temperatura sarà percepibile anche senza termometro.
L’esperimento dello scaldabagno può essere ripreso come esempio di sistema costituito da diversi sottosistemi.
4. Quanti cucchiaini di zucchero deve contenere il sistema soluzione di acqua e zucchero per far galleggiare un oggetto di plastica?
Occorre trovare un oggetto di polistirene (PS) abbastanza compatto e non troppo sottile, altrimenti la presenza delle bollicine d’aria che aderiscono a esso lo faranno salire a galla in anticipo rispetto al raggiungimento della concentrazione di zucchero necessaria.
Quest’ultimo esempio prepara al concetto di variabile.
1. Montare e smontare
Ogni gruppo di allievi riceve uno dei seguenti sistemi:
Il compito degli allievi è di separare ogni sistema in parti più piccole e poi rimetterle insieme.
I bambini scrivono prima i nomi dei sistemi e poi, sotto ciascuno, i nomi dei gruppi di oggetti o disegni delle parti che sono state da loro separate. L’insegnante spiega che questi sistemi, più piccoli di quelli dati, sono sottosistemi. I bambini elencano altri esempi di sottosistemi. La maestra può anche riprendere il sistema "pila-filo-lampadina" e mostrare che la lampadina è formata da altre parti più piccole, come il filamento, la filettatura, il bulbo, mentre il filo risulta formato da più fili di rame e da un rivestimento, e così via.
Può quindi passare a richiedere ai bambini altri esempi di sottosistema presi dalla loro esperienza quotidiana. Ecco alcuni esempi:
2. Trovare tutte le possibili combinazioni che fanno accendere la lampadina, usando il gioco del circuito e il sistema filo-pila-lampadina.
3. Costruire un gioco del circuito, incollando strisce di alluminio, e chiuderlo bene. Riuscirà il compagno a scoprire tutti i collegamenti?
4. Quali sono i sottosistemi del gioco delle lame rotanti?
5A. Un sacchetto da thè contiene un sale di rame colorato e un bicchiere con acqua. C'è interazione fra l’acqua e il sale colorato? Il sistema ottenuto è una soluzione o una non-soluzione? Come si recupera il “sottosistema” sale dalla soluzione?
Il sale colorato è cloruro rameico. Si aprono i sacchetti del tè e si riempiono con un cucchiaino di tale sale. Il sacchetto richiuso costituisce un sottosistema del sistema più grande comprendente anche l’acqua. Il sale è recuperabile tramite evaporazione su una superficie larga.
5B. Quanti sottosistemi si originano nell’interazione tra la soluzione del sale colorato e l’alluminio? Che trasformazioni subiscono?
I sottosistemi inizialmente sono la soluzione azzurra e l’alluminio (ottimo quello delle vaschette da forno tagliate a strisce). Dopo l’interazione, lasciando tutto a riposo, si potranno osservare tre o quattro sottosistemi: l’alluminio che risulterà scurito e notevolmente corroso; la soluzione che non sarà più azzurra ma incolore o appena grigiastra e calda; una polvere marrone scura che non era presente all’inizio e che si deposita sul fondo e alcune bollicine di un gas.
La spiegazione delle trasformazioni chimiche inizia da questo tipo di osservazione delle diverse sostanze materiali coinvolte nell’interazione. Confrontando questa esperienza con la precedente, i bambini possono rilevare un tipo di trasformazione più profonda in cui si sono originati nuovi materiali dai vecchi (ora il sale di rame colorato non è più recuperabile). Questo tipo di trasformazione si dice “chimica”. Non occorre andare avanti con spiegazioni più approfondite, ma può essere opportuno cercare altri esempi comuni in cui i materiali subiscono simili radicali e irreversibili trasformazioni (ferro a ruggine, seme a foglie verdi, legno a carbone, ecc.)
6. Quali sono i sottosistemi che compongono un seme dicotiledone? Quali sono necessari alla crescita?
I gruppi di lavoro hanno a disposizione semi di fagiolo conservati a bagno per 24-48 ore, una lente d'ingrandimento, una pinzetta, dei bicchieri con cotone inumidito per le prove di semina. I bambini disegneranno i due cotiledoni, l'embrione la membrana esterna. La maestra chiederà ai bambini di descrivere la struttura del seme. Se si semina ogni singola parte separatamente si avrà la crescita? (Solo la combinazione cotiledone + embrione darà luogo alla crescita).
7. Costruzione di un’automobile
Occorre una confezione di costruzioni (per esempio Lego) predisposta per realizzare un’automobile giocattolo, completa di immagini che guidano la realizzazione.
Ogni gruppo di bambini costruisce una parte (sottosistema) dell’automobile, ricevendo solo i pezzi necessari e la fotocopia con le immagini che mostrano la parte da montare. Alla fine i “sottosistemi” sono montati insieme per formare il sistema completo.
8. Costruzione di un puzzle
Occorre partire da un puzzle montato da 250 pezzi, tenuto tra due fogli di cartone, capovolgerlo e dividerlo in cinque parti. I cinque settori possono avere anche forme complesse, il cui contorno viene ricalcato su un foglio A3 o A4. Si contrassegnano i pezzi adiacenti, sul retro, con cinque colori diversi, quindi si assegna a ciascun gruppo di bambini il “sottosistema” smontato dei pezzi di un dato colore e il foglio con il profilo della loro area. Ogni gruppo costruirà il proprio sottosistema entro tale profilo, avendo a disposizione la fotocopia dell’intero soggetto, quindi si monterà il tutto sul tavolo grande.
1. Qual è la proprietà che cambia?
Fornire uno dei seguenti gruppi di oggetti ad ogni gruppo di allievi:
Si chiede ai bambini di numerare e ordinare gli oggetti in base alla maggiore o minore grandezza della proprietà trovata e la maestra scriverà alla lavagna i nomi di tali proprietà su una linea continua dal – al +.
Per esempio:
1 2 3 4
- profumato…………..+ profumato variabile = profumo
La maestra spiega che quando una proprietà può cambiare viene chiamata variabile. Stimola quindi la produzione di altri esempi (altezza dei bambini, colore delle foglie ecc.). Per mostrare una variabile nel tempo prende un accendino trasparente e traccia col pennarello un segno al livello del liquido. Quindi apre al massimo la piccola ruota dentata e fa uscire il gas fino ad avere una consistente diminuzione di livello. Chiede ai bambini quali sono le variabili. Oppure accende un bastoncino di incenso e lo appoggia in posizione leggermente obliqua e chiede nuovamente quali variabili si possono individuare.
2. Trovare tutte le parole che si possono comporre con almeno due lettere a scelta
Annotare le parole e contare le lettere che compongono le parole. La variabile è il numero di lettere delle parole. Con questi dati costruire un istogramma.
Ogni gruppo di bambini riceve una striscia con la scritta ISTOGRAMMA, ritaglia le lettere e le usa per comporre parole formate da due o più lettere. Ogni parola trovata viene scritta sul quaderno. L’istogramma va costruito usando la frequenza delle parole di due, tre, quattro lettere ecc. Con questo gioco i bambini apprendono la costruzione dell’istogramma. Si può ripetere il gioco scegliendo altre parole lunghe. Le parole lunghe possono anche essere suggerite dai bambini. A casa gli allievi costruiranno altri istogrammi, giocando con le parole lunghe, scelte dal libro o dai giornali.
3. Quali sono le variabili nelle patate portate dalla maestra? Disegnare l’istogramma per una variabile
L’insegnante porta un sacchetto di patate e ne distribuisce cinque a ciascun gruppo, curando che le patate assegnate siano ben diverse tra loro. La maestra chiede cosa hanno di diverso le patate e i bambini osserveranno che tali patate hanno diverse dimensioni, forma e peso. La maestra chiederà di metterle in ordine per una variabile e di numerarle. Quindi chiederà ai bambini per quale variabile può essere utile la bilancia. I gruppi peseranno a turno le loro patate, una per volta, e registreranno il numero della patata e il peso in una tabella. Quindi, per mezzo di un righello, ritaglieranno delle strisce di carta lunga ciascuna tanti millimetri quant’è il peso in grammi della patata, numereranno e coloreranno diversamente tali strisce, quindi le incolleranno affiancate verticalmente dalla più corta alla più lunga. Avranno realizzato così l’istogramma della variabile “peso”.
4. Le variabili degli alberi del bosco
In una visita al giardino della scuola, oppure al giardino o boschetto comunale, con l’aiuto della maestra, ciascun gruppo di bambini contrassegnerà, con foglietti dello stesso colore, ciascun albero di una stessa specie. Quindi su tali foglietti si scriveranno le variabili (tipo di corteccia, circonferenza e diametro del tronco, mentre una foglia dell’albero potrà essere incollata sul retro per controllare l’identità della specie. Completato il giro delle misure e raccolti tutti i cartoncini, si torna in classe dove questi saranno raggruppati per colore, controllati e allineati in un cartellone, per formare le barre dell’istogramma della variabile popolazione. Ogni gruppo dovrà riferire le proprietà osservate nella propria specie di albero. I dati scritti sui cartoncini potranno essere usati per costruire altri istogrammi relativi alla variabilità delle dimensioni di ogni singola specie.
5. Quale acqua contiene più sali disciolti?
Utilizzare un tipo di acqua minerale con elevato contenuto salino, uno con scarso contenuto salino e acqua di rubinetto (che ha contenuto di sali intermedio). Prima di iniziare l’esperimento la maestra mostra ai bambini il residuo dell’evaporazione dell’acqua lasciata al sole o sul termosifone. È importante fare in modo che siano i bambini stessi a proporre, per risolvere il problema, di partire da un’uguale quantità di acqua di ciascun tipo. Si prelevano 30 gocce dell'acqua di rubinetto e 30 gocce di acqua con alto contenuto di sale. Si versano sul fondo di due bicchieri capovolti e si lasciano evaporare. Le chiazze biancastre del residuo salino avranno dimensioni nettamente diverse.
6. Registrare con un istogramma la variabile ritmo delle pulsazioni cardiache nei diversi momenti della giornata e con un altro istogramma il ritmo di tutta la classe preso nello stesso momento
Nel primo caso le pulsazioni possono essere prese a intervalli di un’ora dal mattino alla sera e registrati il giorno dopo a scuola. Nel secondo caso si raggruppano i valori di pulsazione dei bambini che ricadono, ad esempio, tra 66 e 70, tra 71 e 75, ecc. e si costruisce l’istogramma con i valori delle ricorrenze in tali intervalli.
7. Come variano nel tempo la temperatura esterna e quella dell'aula?
Conviene avere un termometro interno e uno esterno fissi, per registrare tutte le temperature dell'anno. Le temperature verranno registrate su un apposito istogramma. Ogni mattina, prima dell'inizio della lezione, un bambino leggerà la temperatura interna e l'annoterà sull'istogramma predisposto. Un secondo bambino si occuperà della temperatura esterna e la indicherà sullo stesso istogramma, con un diverso colore. Si può usare un cartellone, appeso alla parete, in modo che sia visibile da tutti. I dati possono essere registrati anche su foglio elettronico.
8. Quali variabili puoi registrare per seguire la crescita della piantina?
Ogni gruppo semina tre o quattro semi identici (fagiolo, erba medica, grano o altro) in un bicchiere con un po’ di terra. Ogni gruppo segue lo sviluppo della pianta che germina per prima, registrando settimanalmente l’altezza del fusto, il numero di foglie e altre variabili e scarta le altre piantine.
Gli istogrammi possono essere costruiti indicando il numero di foglie o l’altezza presenti dopo una, due, tre ecc. settimane. Ovviamente si contrassegnano i diversi bicchieri e si idratano regolarmente.
9. Costruire un istogramma con le ampiezze del palmo della mano dei bambini della classe
I bambini misureranno l’ampiezza del palmo della mano, dal mignolo al pollice, dopo averlo ricalcato su un foglio con una matita, e scriveranno il risultato in centimetri. Con i dati a disposizione si costruirà l'istogramma in cui l’altezza delle barre indica la ricorrenza di ogni misura d’ampiezza.
In questa sezione sono trattati i concetti chiave di sottosistema, variabile, modello, energia.
La classe quarta ripartirà da alcune esperienze, da scegliere, sul concetto di sistema e sul concetto di sottosistema, quindi seguirà un percorso simile a quello illustrato per la classe terza, con esperienze sul concetto di variabile e misura, e infine si introdurranno i concetti di modello ed energia, che saranno poi ripresi e sviluppati per intero nella classe quinta.
In classe quarta il concetto di variabile potrà essere affrontato fin dall’inizio a un livello di maggior complessità, prevedendo situazioni in cui si presentano più variabili interdipendenti in gioco. Subentra quindi il problema di controllare le variabili stesse (stabilire quali mantenere costanti in prove comparative) e di riconoscere le correlazioni. La correlazione non è altro che l’interdipendenza tra due variabili: la variazione della variabile A è associata alla variazione della B. Questo può avvenire in due modi principali: all’aumentare di A, B aumenta, oppure all’aumentare di A, B diminuisce. A seconda dei casi si parla perciò di correlazione diretta e inversa oppure, che è lo stesso, positiva o negativa.
Alcune esperienze sul concetto di modello condotte nelle classi quarte sono riportate in questa pagina.
1. Quanta soluzione di sapone deve essere aggiunta nel “sistema acqua”, formato da acqua e sali minerali, per avere la produzione di schiuma stabile?
Per fare la soluzione di sapone si sciolgono circa cinque grammi di sapone di Marsiglia in cinque litri di acqua deionizzata. L’acqua potabile si preleva con un bicchiere che funge da misurino e si pone in un barattolo trasparente, da almeno mezzo litro, con tappo a vite. Con un misurino più piccolo (10-20 mL) si aggiungono aliquote successive di acqua saponata, chiudendo il barattolo e provando ogni volta ad agitare per vedere se si forma la schiuma. Si conta il numero di misurini di acqua saponata necessari per avere una schiuma stabile per trenta secondi. Si può provare con acqua di rubinetto, con acqua lievissima (basterà un misurino di acqua saponata) o con acqua Ferrarelle (ne occorreranno molti di più). I sali contenuti nelle acque potabili interagiscono col sapone “bloccandolo”, e impedendogli di formare la schiuma. Il deposito opaco e torbido che si nota sul fondo del barattolo è il risultato dell’unione dei sali col sapone. Più sali sono contenuti nell’acqua, più sapone è necessario aggiungere per ottenere la schiuma; più acqua potabile si preleva, più acqua saponata si dovrà aggiungere per ottenere lo stesso risultato (due esempi di variabili interdipendenti). I sottosistemi in gioco sono dunque tre: sali minerali, sapone, acqua. Tale esperimento può essere utilizzato come esempio per introdurre, successivamente il concetto di variabile (numero dei misurini di acqua saponata, volume di acqua potabile, contenuto salino delle varie acque).
L’esperienza 5 sulla variabile della classe terza può essere effettuata in parallelo come conferma.
2. Con una pila da torcia, due fili e una mina per matita, costruisci un sistema “scaldabagno” capace di scaldare l’acqua.
In questo caso i bambini hanno a disposizione anche un termometro. Il circuito va montato come nell’analogo esperimento con la pila il filo e la lampadina, ma in questo caso l’uso di due fili semplifica l’operazione. I due fili sono attorcigliati alle estremità della mina, immersa in acqua. Quando è tutto pronto si collegano le estremità libere dei fili ai due poli della batteria e la mina diventerà calda. Occorre una batteria da torcia da 1,5 V delle più grandi o una piatta da 4,5 V per avere un’erogazione abbastanza prolungata di calore e una mina da disegno. L’innalzamento di temperatura (proprietà variabile) sarà misurato con il termometro a intervalli regolari di due minuti.
L’esperimento dello scaldabagno, oltre a illustrare i concetti di sistema e sottosistema, potrà può essere ripreso come esempio di variabile (temperatura) tracciabile come istogramma, e infine anche per introdurre il concetto di energia.
3. Quanti cucchiaini di zucchero deve avere il sistema soluzione acqua e zucchero per far galleggiare l’oggetto di plastica?
Occorre trovare un oggetto di polistirene (PS) abbastanza compatto e non troppo sottile, altrimenti la presenza delle bollicine d’aria che aderiscono ad esso lo faranno salire a galla in anticipo rispetto al raggiungimento della necessaria concentrazione di zucchero.
Per quanto riguarda l'esplorazione e l'introduzione del concetto di variabile, si possono utilizzare le esperienze descritte per la classe terza e altri esempi simili di facile realizzazione.
Applicazione del concetto di variabile
Si scelgono alcune esperienze descritte per la classe terza, per far sì che i bambini apprendano come costruire gli istogrammi.
In aggiunta si propongo le seguenti altre attività.
1. Qual è la temperatura più alta che si può raggiungere con la “polvere riscaldina” e l’acqua?
Occorre una bilancia digitale al grammo e, per ogni gruppo, un misurino per l’acqua, un termometro, un bicchiere da bar di polistirolo ed uno di plastica inseribile in quello di polistirolo, la polvere di cloruro di calcio anidro dei sacchetti dei ricambi per deumidificatori (mantenere sigillati). I diversi gruppi di bambini potranno registrare gli innalzamenti di temperatura ottenuti unendo quantità variabili di “polvere riscaldina” a quantità variabili d’acqua. L’aumento di temperatura è correlato positivamente con la quantità di polvere e negativamente con la quantità di acqua.
Se si riprenderà quest’esperienza come esempio per introdurre il concetto di calore, occorrerà tenere presente che la quantità di energia termica liberata dipende solo dalla quantità di polvere che si scioglie in acqua e non dalla quantità d’acqua usata.
2. Quante variabili si possono trovare usando la molla colorata?
Nei negozi di giocattoli si vendono delle molle di plastica di circa 6 cm di diametro formate da molte spire piatte. Questa molla è l’ideale per illustrare le variabili e la dipendenza tra esse. Con un fermaglio grande si può realizzare un gancio assicurato all’ultima spira, a cui appendere la stessa scatola della confezione con un filo. Mentre un righello può essere infilato trasversalmente per sorreggere un numero qualsiasi di spire, libere di oscillare verticalmente.
La prima variabile che può essere studiata (non occorre attaccare la scatola né il righello, basta tenere la molla e imprimere delle oscillazioni verticalmente, più o meno ampie) è il ritmo delle oscillazioni che cambia al variare del numero di spire libere. I bambini possono battere le mani all’unisono per rendersi conto delle variazioni di ritmo, anche senza cronometrare il tempo. Inoltre si può variare l’ampiezza delle oscillazioni lasciando costante la variabile numero di spire. Sorprendentemente, in questo caso il ritmo resta invariato. Si può quindi fissare la molla al righello e bloccare questo con dei pesi su un piano o sulla parte alta della lavagna. Si assicura la scatola in modo da realizzare una specie di bilancia a molla e si sceglie un numero di spire tale da far rientrare la scatola oscillante all’interno della parte utile della lavagna. In questo secondo esperimento si varia il numero di monetine da uno o due centesimi, o altri oggetti uguali di peso analogo, che si introducono nella scatola, e si segna la posizione della scatola col gessetto a ogni aggiunta successiva. La variabile peso risulta così correlata positivamente alla variabile lunghezza (o meglio allungamento). Il dispositivo a molla può essere usato per far indovinare il numero di oggetti nella scatola.
3. Qual è la “Catapulta” con la massima gittata?
I bambini osservano delle “catapulte”, realizzate con delle mollette di legno da bucato montate su dei cunei di legno, per individuarne le variabili. Tali catapulte differiscono per la lunghezza del braccio di lancio, per l’angolo di apertura e per l’altezza da terra dei cunei. In alternativa si possono rendere variabili questi parametri su una stessa catapulta, a disposizione per ciascun gruppo di bambini. Un’altra variabile sarebbe la dimensione della pallina da lanciare, ma dovranno essere i bambini stessi a stabilire che tutte le prove di gittata si dovranno effettuare con la stessa pallina per ragioni di equità. In questo esperimento si possono introdurre anche i concetti di variabili indipendenti (variabili costruttive delle catapulte, peso della palla da lanciare) e di variabile dipendente (gittata). Quando i bambini avranno ipotizzato quali variabili hanno maggior rilevanza sulla gittata, e stabilito quale catapulta dovrebbe effettuare i lanci più lunghi, potranno effettuare la gara tra le stesse catapulte o tra i gruppi per avere conferma diretta delle loro ipotesi.
4. Da quale variabile dipende maggiormente il ritmo di oscillazione del pendolo?
Sono necessari fili di nylon di due diverse lunghezze (per esempio 50-100 cm), piombi da pesca da 10 e da 20 g e un orologio o cronometro.
Le variabili in input sono la lunghezza, il peso e l'ampiezza delle oscillazioni. Le variabili in uscita il ritmo delle oscillazioni, ottenibile per esempio contando il numero di oscillazioni in trenta secondi.
I bambini dovranno effettuare tali misure del ritmo, o frequenza, di oscillazione, fissando i pesi ai fili e ponendoli in oscillazione sorreggendoli a un’estremità. Con prove comparative in doppio (stessa lunghezza e ampiezza e diversa massa, stessa massa e ampiezza e diversa lunghezza, stessa massa e lunghezza, ma diversa ampiezza), stabiliranno che il ritmo è correlato in modo inverso alla lunghezza. Effettuando le prove comparative con i due pendoli che oscillano contemporaneamente non sarà necessario controllare il tempo, ma basterà vedere quale pendolo ritarda o se le oscillazioni sono sincrone.
5. Quali sono le variabili che influiscono sull’ arrugginimento del ferro?
Sono necessari una paglietta di ferro (tipo grigio scuro), tubi di plastica o vetro trasparenti di due lunghezze diverse ma con medesima sezione (per esempio provette o tubi sigillati a un’estremità con silicone), aceto, sale, pinze per sostenere i tubi, un pennarello indelebile e, opzionalmente, una bilancia al grammo per pesare quantità circa uguali di paglia di ferro.
Si incastra un pezzo di paglia di ferro sul fondo dei tubi aventi dimensioni variabili e si capovolgono gli stessi tubi in bicchieri con due dita d’acqua (imboccatura in basso, ferro in alto). Inizialmente si segna il livello raggiunto dall’acqua all’interno del tubo, con pennarello indelebile. La paglia di ferro può essere bagnata con sola acqua, con aceto o con acqua e sale (sono queste altre variabili, in aggiunta alla lunghezza del tubo). Si misura a distanza di ore l’innalzamento dell’acqua all’interno dei tubi, causato dal consumo di aria da parte del ferro, che diviene marroncino in alcuni punti. La velocità di arrugginimento è valutata in base alla rapidità della crescita del livello dell’acqua all’interno dei tubi. La crescita maggiore si ha bagnando il ferro con aceto e sale. Se non si mette neppure acqua, la trasformazione richiede diversi giorni. La trasformazione si arresta quando è stato consumato tutto l’ossigeno e l’acqua è salita fino a circa un quinto dell’altezza del tubo, in proporzione al contenuto di ossigeno dell’aria (21%). Le altezze raggiunte in ogni provetta si possono riportare in un grafico.
In questa sezione sono trattati i concetti chiave di energia e modello.
Le attività relative ai concetti di energia e di modello possono essere collocate flessibilmente in un percorso che parte dalla quarta elementare e arriva alla scuola media, selezionandole in base al loro livello di complessità.
Il concetto fisico di energia non può essere definito accuratamente a livello di scuola primaria, ma il suo uso nella vita quotidiana e nelle scienze è talmente diffuso che deve essere incluso tra i concetti chiave. Ci sono diversi aspetti connessi a tale concetto che possono essere ben compresi e applicati correttamente dai bambini e dall’insegnante, senza rischiare di commettere errori o di creare misconcezioni, pertanto l’energia assolve al ruolo di organizzatore mentale per l’alfabetizzazione scientifica. Gli aspetti fondamentali dell’energia adatti alla scuola primaria sono riassunti nella mappa concettuale1 che dice innanzitutto che l’energia non ha peso, non è un fluido né un materiale.
Inoltre si nota che sistemi possiedono varie forme di energia e la scambiano tramite lavoro o calore. Pertanto, il calore e il lavoro non sono forme di energia, come comunemente si insegna, ma quantità di energia trasferita con date modalità (il calore a causa di differenze di temperatura e il lavoro a causa di forze non equilibrate). Quindi un sistema può essere caldo (cioè essere a temperatura elevata) ma non può “possedere calore”. Il calore è definito per un processo di “travaso” di energia che avviene nel tempo e non per un sistema “fermo” nel suo stato.
Le forme di energia che un sistema può possedere sono innumerevoli (la mappa mostra solo alcuni esempi comuni), ma tutte sono costituite da due componenti universali: energia cinetica (posseduta dai corpi in movimento) ed energia potenziale (energia accumulata, in forma più o meno provvisoria, all’interno di sistemi capaci di modificare la propria struttura). L’energia interna di un sistema è la somma di tutte le varie forme di energia da esso possedute.
L’energia viene spesso classificata in base alle diverse fonti, o sorgenti (muscolare, solare, chimica, elettrica, nucleare, eolica, sonora, ecc.). Ogni sorgente segna la fase iniziale della catena energetica, altro concetto fondamentale. L’energia fornita o prodotta dalla sorgente è in genere trasmessa, attraverso un mezzo, ad un sistema che deve utilizzare tale energia (utilizzatore). Il sistema utilizzatore in genere trasforma l’energia in altre forme utili, che ne consentono l’utilizzo.
Durante la trasmissione e l’utilizzo, l’energia si degrada, ovvero si disperde in altre forme senza però mai distruggersi. La catena si conclude con tale fase di dispersione a forme di energia inutilizzabili. Tutti i processi di interazione e trasformazione dell’energia comportano una parziale dissipazione di energia. Per comprendere come l’energia possa cambiare forma il prerequisito è il concetto di conservazione. Questo concetto non può essere affrontato in termini quantitativi se non a partire dalla scuola media. Alle elementari il concetto di conservazione si può solo inquadrare, per esempio, col semplice esempio della bolletta energetica, dove si paga l’energia in base alla quantità totale assorbita, indipendentemente dagli utilizzi che se ne fanno e che possono essere i più diversi. Anche l’analogia delle forme di ricchezza totale (risparmi, immobili, liquidi ecc.), che possono essere convertite senza modificare l’ammontare totale, può aiutare a comprendere la conservazione nelle “transazioni” tra le varie forme di energia.
In sintesi l’idea di energia che gli allievi possono ricavare, al livello della primaria, è che essa “misuri” la capacità di provocare trasformazioni nei sistemi. Le virgolette indicano che non esiste, praticamente, uno strumento che misura direttamente l’energia, analogo a un termometro per la misura della temperatura.
Alcune esperienze proposte per le medie prevedono una determinazione indiretta dell’energia in joule o in calorie tramite misure di variazioni di temperatura. Tutte le altre esperienze sono qualitative. In questa forma, il concetto di energia è un’estensione di quello di interazione: non c’è trasferimento di energia tra due sistemi senza interazione, e non c’è interazione che non comporti scambio energetico.
Tra le attività proposte ce ne sono alcune che evidenziano le interazioni a distanza e il trasferimento di energia ad esse associato.
Come il concetto di energia, quello di modello può essere proposto a partire dalla quarta elementare. Alcune attività, con le macchine operatrici, si possono iniziare anche nel primo biennio. Il percorso prosegue poi nella scuola media (modello particellare, modelli delle trasformazioni chimiche, macchine operatrici complesse, riconoscimento di pattern, studio di modelli matematici dei fenomeni). In alternativa l’intero percorso potrebbe essere avviato direttamente nella scuola media.
Alcune esperienze sul concetto di modello condotte nelle classi quinte sono riportate in questa pagina.
I gruppi hanno a disposizione una pila piatta da 4,5 V, una lampadina, un motorino elettrico con ventilatore collegato a una lampadina LED, una trottola, un'automobilina con carica a molla o a volano, uno jo-jo, un dischetto bimetallico “saltatore”, una palla “matta”.
Gli allievi devono produrre delle interazioni con gli oggetti assegnati e scrivere tutte le evidenze sul quaderno.
Un’interazioni non ovvia è quella con il motorino elettrico attaccato al ventilatore e collegato alla lampadina LED. Soffiando con forza sulla ventola questa si pone in rotazione e si accende la lampadina per un istante, purché sia collegata con la giusta polarità. Se non dovesse illuminarsi invertire le polarità o il senso di rotazione dell’elica. Sia nel caso dello jo-jo, sia in quello della palla matta, l’interazione avviene nel brevissimo intervallo di tempo in cui i due oggetti si fermano nel punto più in basso, prima di risalire.
L’insegnante scrive alla lavagna tutte le evidenze delle interazioni rilevate dai gruppi durante l’esplorazione. In tutti i fenomeni di interazione esplorati c’è una sorgente, un trasferimento, un utilizzo, una degradazione. La causa di queste trasformazioni, che si trasferisce nelle interazioni, da un sotto-sistema all’altro, è chiamata energia. Per illustrare la catena energetica l’insegnante riordina le osservazioni dei gruppi di lavoro, chiedendo loro di precisare, caso per caso, quale può essere la sorgente, il mezzo di trasmissione o trasporto, quale l’utilizzatore e in quali forme si manifesta la degradazione dell’energia. Per rinforzare il concetto l’insegnante apre un fermaglio e lo piega ripetutamente. Gli allievi ripeteranno l’esperimento e sentiranno sulle labbra che il fermaglio si è riscaldato. Nell’interazione con le mani si è trasferita energia al fermaglio. L’aumento di temperatura testimonia che l’energia interna del fermaglio è aumentata. Dopo pochi secondi il fermaglio non sarà più caldo perché l’energia si trasferirà all’aria che lo circonda, disperdendosi.
Si chiede agli allievi di portare ulteriori esempi di forme di energia e di trasformazioni di energia. Per esempio:
1. Come si può osservare il trasferimento di energia lungo una barra di metallo usando una sorgente di calore e una candela?
Il materiale per questa esperienza può essere manipolato solo dall’insegnante, dopo aver discusso le varie ipotesi di soluzione con la classe. Occorrono una lamina di metallo (per esempio un righello di alluminio) o un filo metallico rigido di almeno 20 cm, una candela, un sostegno per attaccare la lamina o il filo orizzontalmente, una candelina tagliata a fettine.
Si predispongono dei cubetti di cera fondendoli parzialmente e poi lasciandoli raffreddare a distanze regolari (circa 2 cm) sulla barra metallica. Se si usa il filo si infilano delle “fette” di candela a mo’ di spiedino. Si blocca il filo o la barra orizzontalmente con un sostegno (la barra con i pezzi di cera rivolti verso il basso) e si inizia a riscaldare l’estremità opposta con una candela, avviando contemporaneamente il cronometro. Si annotano i tempi successivi a cui avviene la caduta dei pezzi di cera. Si può costruire una tabella delle distanze e dei tempi di fusione, o un grafico in coordinate rettangolari, con il tempo sull’asse orizzontale e la distanza dalla fiamma sull’asse verticale. Gli intervalli di tempo tra una caduta e l’altra non risulteranno costanti, ma sempre crescenti. Le domande da porre sono:
2. Se si versano in un bicchiere di acqua alcuni cubetti di ghiaccio posti in un sacchetto di plastica, come varia la temperatura?
Per l’esperimento occorrono un bicchiere, un termometro ad alcol e alcuni cubetti di ghiaccio in un sacchetto.
Gli allievi devono misurare la temperatura dell'acqua e ghiaccio, ogni minuto, e annotarla sul quaderno. Quando il ghiaccio sarà completamente fuso, si costruisce l'istogramma con i dati delle temperature. Se gli allievi hanno acquisito abbastanza confidenza con le coordinate rettangolari (gioco della battaglia navale) potranno realizzare un grafico in tali coordinate, ponendo sull’asse orizzontale la variabile tempo (1, 2, 3… minuti) e sull’asse verticale le temperature (0, 1, 2, 3…25 °C). I punti saranno collegati da una linea curva più “liscia” possibile. Si consiglia questa seconda soluzione per preparare gli allievi allo studio delle correlazioni tra coppie di variabili.
Questo semplice esperimento ci consente anche di chiarire alcuni errori concettuali assai diffusi.
3. Quale materiale tra quelli assegnati permette il miglior trasferimento di calore?
Il materiale occorrente, per ogni gruppo, è: acqua calda o fredda, un bicchiere di polistirolo espanso, uno di plastica, una lattina d'alluminio, termometri, un foglio di alluminio. Gli allievi devono aver già effettuato il precedente esperimento 2 per avere un’idea di come si seguono le variazioni di temperatura.
Si distribuisce la stessa quantità di acqua calda (o fredda) nei tre recipienti e si legge la temperatura a intervalli di tre minuti, riportando il tempo sull'asse orizzontale e la temperatura su quello verticale. Si confrontano le tre curve di raffreddamento o di riscaldamento. Gli allievi disegnano schematicamente i bicchieri e delle frecce che rappresentano la direzione del flusso di energia; quindi rispondo a domande del tipo:
4. Quale tipo di superficie assorbe maggiormente l’energia luminosa?
L’insegnante prepara in precedenza due lamine metalliche di rame o alluminio, una normale e una completamente annerita con il fumo di una candela. Poiché sarà necessario utilizzare una fonte di luce, l’esperimento non potrà essere effettuato da ogni gruppo. La fonte di luce può essere una lampadina da almeno 60 W. Le due lamine e il vetro o lo specchio, possono essere messi sul fondo dei bicchieri, che serviranno anche per sostenere il termometro, che si appoggerà col bulbo sulla lamina. Per questo esperimento è preferibile utilizzare un termometro digitale, il cui display potrà essere seguito da tutta la classe. Conviene lasciare la lampada fissa e spostare i bicchieri sotto di essa, tenendoceli per un tempo fisso e osservando l’aumento di temperatura. La lampada deve essere il più possibile vicina all’orlo del bicchiere, ma esterna ad esso.
Dopo circa un minuto di esposizione alla luce, si riscontrerà una netta differenza di temperatura anche solo appoggiando sulla mano le lamine e il vetro. Il risultato è identico anche se si ricoprono i bicchieri con una lastra di vetro, ma non se si ricopre la lampadina con un foglio di alluminio (v. domande successive); questo dimostra che è la luce e non l’aria calda che trasporta l’energia. Gli allievi registreranno tutte le osservazioni e risponderanno alle seguenti domande:
5. Due recipienti contengono acqua a temperature diverse; se si mescolano due quantità uguali d'acqua, qual è la temperatura finale?
Dopo aver discusso le ipotesi di lavoro e precisato le variabili da misurare, gli allievi dei vari gruppi preleveranno in due bicchieri di polistirolo quantità uguali di acqua calda e di acqua fredda da due brocche d'acqua preparate dall’insegnante. Ciascun gruppo disporrà inoltre di un termometro, col quale misurerà le temperature iniziali e quella finale, risultante dal mescolamento. Se le quantità di acqua miscelate erano uguali, la temperatura dovrà risultare intermedia a quelle di partenza. Quindi l’insegnante farà domande del tipo:
L'insegnante farà vedere dalla cattedra, chiamando un allievo per volta, che mescolando quantitativi diversi di acqua si ottengono temperature diverse da quella intermedia. Per esempio, se la quantità d'acqua calda è maggiore, la temperatura finale sarà vicina a quella dell'acqua calda.
6. Come si può riconoscere una pila carica da una scarica, senza usare una lampadina?
Quest’esperienza offre l’opportunità di introdurre il concetto di energia potenziale, che verrà utilizzato anche in future esperienze. L’energia potenziale è energia “congelata” o in “deposito”, che non provoca effetti per tempi indeterminati, finché non si innesca un’interazione di qualche tipo. Le due batterie, apparentemente identiche, differiscono per il contenuto di energia potenziale. Il vassoio di ciascun gruppo dovrà contenere: due pile da 4,5 V, una nuova e una completamente scarica, filo di rame, bussola, bicchiere con acqua e sale.
Collegando per pochi secondi i due poli della pila carica si avranno diversi effetti: il filo si riscalda, l'ago della bussola posta nelle vicinanze subisce una deviazione. È importante evidenziare la propagazione a distanza dell'interazione. Bagnando le lamine della pila capovolta sull'acqua salata, si osserverà il formarsi di bollicine. Le domande da porre sono:
7. Qual è la massima temperatura che si riesce a raggiungere con “polvere riscaldina” e acqua?
I gruppi disporranno di un vassoio con un bicchiere di cloruro di calcio anidro (sacchetti del ricambio per deumidificatori, da sigillare dopo l’uso altrimenti il prodotto non sarà più efficace in seguito), un cucchiaio, un bicchiere d’acqua, un contagocce, un bicchiere di polistirolo da caffè e un termometro.
Gli allievi potranno variare le dosi di polvere “riscaldina” e acqua, registrandole accuratamente e misurando ogni volta l’aumento massimo di temperatura. Se sceglieranno di usare il bicchiere di polistirolo otterranno incrementi maggiori di temperatura. Gli allievi devono sapere che l’energia non si può creare, e che quindi prima di sviluppare calore doveva esserci dell’energia potenziale nei materiali (sottosistemi) uniti. Pertanto si rivolgono loro le seguenti domande:
L’energia chimica è quella che si può ottenere dall’interazione di materiali (per esempio legno più aria e benzina più aria).
8. Con le lamine di rame e di alluminio e carta assorbente costruire una pila capace di far accendere la lampadina
Anche in questo caso si assisterà alla trasformazione di energia potenziale in altre forme “attive” di energia. Ovviamente dovrà essere l’insegnante a illustrare la corretta disposizione delle lamine dopo averla provata personalmente. Ogni gruppo dispone di una dozzina di lamine piatte di rame (va bene anche quello delle grondaie) e altrettante di foglio d'alluminio per alimenti, di dimensioni uguali (per esempio 2x3 cm). Carta assorbente da cucina ripiegata; bicchiere con aceto e sale. Vassoio di plastica o legno. Lampadina LED. L’insegnante ha a disposizione una batteria da 9V scarica con l’involucro aperto. La successione rame/alluminio/carta inumidita può essere stratificata più facilmente in orizzontale, così che gli strati siano ben separati. Dopo 4-5 elementi ripetuti si superano già i 2 V, sufficienti per far accendere il diodo LED (le correnti in gioco sono troppo piccole per far illuminare una lampadina a incandescenza). È importante che i tamponi imbevuti di acqua salata e aceto non si tocchino l'uno con l'altro e che non lascino fuoriuscire liquido in eccesso. Il polo positivo del diodo LED, riconoscibile per il piedino più lungo, deve essere collegato al polo di rame.
Si può anche costruire una pila grande come l’intera classe: tra due bambini adiacenti il contatto è formato da un pezzo di alluminio sovrapposto ad uno di rame, tenuti fermi al centro da un fermaglio. I bambini si inumidiscono i polpastrelli del pollice e dell’indice delle due mani con l’acqua salata, quindi si mettono in contatto tenendo tutti il rame con la sinistra e l’alluminio con la destra (o viceversa). Alle due estremità della catena si misurerà un voltaggio tanto più elevato quanto maggiore è il numero dei bambini e delle coppie metalliche. Nell’esperienza i bambini possono costrure vari tipi di “pile umane” a tentativi, cambiando di volta in volta il modo di alternare lamine di rame e alluminio.
Le domande da porre sono:
9. Le celle fotovoltaiche convertono l'energia luminosa in energia elettrica. Realizzare un circuito capace di azionare un motore elettrico.
A ogni gruppo sono forniti una cella fotovoltaica, un motorino elettrico, filo elettrico e nastro adesivo, piccoli oggetti da sollevare (viti, dadi), dischi a settori colorati stampati su cartoncino da ritagliare. Portare in classe una lavagna luminosa o una lampada da 60 W, nel caso dovesse scarseggiare la luce solare.
In questa attività si ha una tripla trasformazione dell'energia: da luminosa a potenziale (quando il circuito della cella fotovoltaica è aperto), da potenziale a elettrica e da elettrica a cinetica. Vanno evidenziate anche altre forme: sonora (il rumore prodotto dal motore) e termica (il motorino si riscalda). Praticamente si ha una vera e propria catena energetica. L'energia luminosa non si affievolisce con la distanza dalla sorgente: l'energia totale è la stessa a qualunque distanza ci si ponga, ma essa si distribuisce su una superficie sempre più ampia, quindi sempre minore è la frazione catturata dalla cella fotovoltaica. Ci sono numerose domande che possono scaturire da questa esperienza. Per esempio:
I bambini dovranno poi schematizzare la catena energetica in ogni caso.
Le esperienze che seguono hanno carattere quantitativo e quindi sono idonee per il livello della scuola media. Esse prevedono l’introduzione delle unità di misura dell’energia più usate: il joule (J) e la caloria (cal). Per acquisire confidenza con tali unità si possono utilizzare le etichette degli ingredienti dei prodotti alimentari, che spesso riportano il contenuto energetico dei cibi in entrambe le unità. Avendo a disposizione diverse di queste etichette si potrà calcolare il rapporto joule/calorie, che risulterà pari a circa 4,2. È importante che gli allievi imparino bene il significato di caloria (anche se quest’unità di misura risulta abolita in tutta Europa dal 1° gennaio 2000, con DPR 802/1982): la caloria è l’energia occorrente per riscaldare un grammo d’acqua di un grado centigrado.
Negli esperimenti seguenti, in cui avverrà l’emissione o l’assorbimento di calore, basterà conoscere la quantità di acqua (in grammi o in millilitri) posta in un bicchiere isolato di polistirolo espanso e la variazione di temperatura da essa subita, per calcolare l’energia transitata in calorie. Le calorie complessive saranno ottenibili dalla moltiplicazione “tutti i grammi di acqua x tutti i gradi di aumento di temperatura di ciascun grammo”. Forniamo l’espressione per il calcolo in questa forma verbale con l’intento deliberato di evitare che gli allievi inizino a memorizzare formule, senza capirne il significato, fin dalle medie. Se si vuole evitare l’uso della caloria, si può fornire il seguente dato:
per aumentare di un grado la temperatura di un grammo d’acqua occorrono 4,2 joule di energia.
Un’altra unità di misura correlata con l’energia, e utilizzata nella vita di tutti i giorni è il watt (W). Esso misura la velocità di utilizzo dell’energia (potenza), in joule al secondo. Una lampadina a incandescenza da 40 W assorbe un’energia di 40 joule per ogni secondo di funzionamento. Una macchina molto potente trasforma molta energia ogni secondo (si parla di kilowatt, cioè migliaia di joule al secondo). Il corpo umano in normale attività consuma circa dieci milioni di joule al giorno (tanto è l’apporto energetico di 2500 kcal). Dato che in un giorno ci sono 86400 secondi, il consumo medio è di circa 120 joule al secondo, cioè 120 watt. L’energia ha un costo. Nella bolletta ENEL, si pagano mediamente intorno a 30 centesimi di euro ogni 1000 kilojoule (circa 0,1 € al kilowattora). Il costo dell’energia dalla combustione della benzina è di circa 4 eurocent ogni 1000 kilojoule, quindi inferiore, ma occorre considerare che se si vuole convertire l’energia della combustione in energia elettrica, con un “generatore”, i rendimenti sono molto bassi, dell’ordine del 20%, senza considerare il rumore e l’inquinamento prodotti in prossimità dell’utilizzatore. Queste considerazioni e la regolarità dell’erogazione elettrica ci dissuadono dall’utilizzo della benzina in casi normali.
10. Esistono in commercio dei bicchieri di cioccolato autoriscaldanti. Quanto calore si trasferisce all’alimento contenuto in questi bicchieri?
Gli allievi dispongono di un bicchiere di cioccolato autoriscaldante, di un termometro ad alcol e di un cilindro graduato da 50 mL (facoltativo, dato che il volume di prodotto è indicato nell’etichetta).
Non conviene svelare il meccanismo di funzionamento del bicchiere se non è stata ancora svolta l’esperienza in cui lo si utilizza per costruirne il modello di funzionamento. Le ipotesi sono comunque ben accette. Per informazione dell’insegnante, tale bicchiere contiene alla base un serbatoio 40 mL di acqua distillata, separati da un’intercapedine di alluminio dall’involucro esterno con scaglie e polvere di cloruro di calcio perfettamente anidro. Premendo sul fondo si rompe la membrana e la soluzione acqua CaCl2 raggiunge i 110 °C. Date le perdite e la distribuzione interna dell’energia, il prodotto da consumare, che non viene a contatto con la soluzione calda, raggiunge circa 50 °C.
Un secondo motivo per non effettuare l’esperimento con i componenti separati è quindi che il termometro ad alcol non può misurare temperature superiori a 60 °C. Il terzo motivo è che, lasciando intatto l’involucro, i ragazzi potranno degustare il prodotto dopo l’esperimento.
Per questa esperienza occorre pianificare bene la procedura da seguire, stabilire cosa misurare e quando farlo. L’insegnate potrà usare un barattolo extra per far vedere agli allievi come funziona.
Una soluzione possibile è la seguente: misurare la temperatura esterna, supposta uguale a quella del prodotto; attivare il meccanismo di riscaldamento, girare una decina di volte, aprire la pellicola e misurare la massima temperatura raggiunta all’interno della massa di cioccolato; quindi misurare il volume del prodotto. Per il calcolo del calore non si compie un grande errore considerando il liquido come se fosse acqua: 4,2 joule per grammo o mL e per grado centigrado. Il calore si calcola moltiplicando l’incremento di temperatura in gradi per il volume del prodotto in millilitri e per 4,2 se si vogliono i joule. Si può anche sostituire il cioccolato con acqua e ripetere l’esperimento in un nuovo bicchiere per confermare.
11. Quanto calore occorre per fondere un grammo di ghiaccio?
L’insegnante predispone una bilancia da cucina con precisione al grammo e una scatola di cubetti di ghiaccio. Ogni gruppo di allievi dispone di un vassoio con un bicchiere di polistirolo espanso con tappo, un termometro ad alcol, un cilindro graduato.
La soluzione più semplice consiste nel misurare l’abbassamento di temperatura, prodotto dalla fusione del ghiaccio in un bicchiere (calorimetro) isolato con un certo volume d’acqua. Gli allievi devono progettare l’esperimento in modo da accelerare la fusione del ghiaccio, per minimizzare le perdite di calore, e riuscire a leggere la temperatura minima raggiunta. Se i cubetti di ghiaccio pesano più di 5-6 grammi conviene usare 100 mL di acqua. Altrimenti 50 mL sono sufficienti. Moltiplicando i grammi d’acqua (comprensivi del ghiaccio) per la variazione di temperatura, si ottengono le calorie richieste per la fusione. Dividendo tale dato per il peso del ghiaccio fuso si ricava il valore specifico per ogni grammo di ghiaccio. Ogni grammo di ghiaccio assorbe 333 joule di energia per la fusione.
12. Quanta energia solare colpisce ogni cm2 di suolo al minuto?
Prima di discutere le ipotesi di lavoro, è opportuno ricordare l'esperienza 4, in cui il metallo annerito era quello maggiormente capace di assorbire l’energia radiante. Il problema può essere reso analogo ai precedenti, ponendo una lamina circolare di rame od ottone, annerita, sul fondo del bicchiere di polistirolo con un volume noto di acqua (5-10 mL). La luce solare può essere diretta perpendicolarmente, verso il fondo del bicchiere, con uno specchio. Si misura la temperatura iniziale e poi ogni 5 minuti dall’inizio del riscaldamento. Una volta determinata l’energia, in calorie o in joule, assorbita dall’acqua ogni minuto, come nei problemi precedenti, si deve dividere per l’area in cm2 del disco nero, per avere l’energia al minuto e al centimetro quadrato. La radiazione solare incidente al suolo, alle nostre latitudini, nelle ore diurne va da un minimo di 0,035 watt/cm2 nel mese di dicembre-gennaio, a un massimo di 0,14 watt/cm2 in giugno-luglio. Con un rapido calcolo si trova che questa energia, sul fondo di un bicchiere da 4 cm di diametro, equivale a 6-25 calorie al minuto, capaci di riscaldare 10 ml d’acqua da un minimo di 0,6 °C/min a un massimo di 2,5 °C/min. I valori trovati con l’apparato sperimentale qui descritto rientrano, in effetti, in quest’intervallo (per esempio da 20 a 25 °C in 5 minuti, in aprile, con lo specchio).
I pannelli solari per la produzione d’acqua calda sfruttano lo stesso fenomeno evidenziato dall’esperimento.
13. Quanti watt (joule al secondo) di energia si possono trasferire dalla batteria all’acqua?
Ogni gruppo di lavoro ha a disposizione un filo al nichel cromo di 0,5 mm di sezione e 50 cm di lunghezza, due fili di rame, una pila piatta da 4,5 V carica, un bicchiere di polistirolo espanso e un termometro. Arrotolando il filo al Ni-Cr a spirale con una matita, si costruisce una resistenza elettrica che, collegata con i capi liberi ai fili e ai due poli della batteria, si riscalderà, e potrà essere immersa a mo’ di scaldabagno in circa 20 mL di acqua. Analogamente alle esperienze precedenti, gli allievi devono preparare il dispositivo, praticare due buchi per far passare i fili dal tappo e un buco per il termometro, leggere la temperatura iniziale, avviare il cronometro nel momento stesso in cui si collegano i due fili alla pila, e leggere la temperatura a intervalli di un minuto, per circa cinque minuti, agitando di tanto in tanto. Se l’incremento di temperatura non si mantiene approssimativamente costante per almeno cinque minuti, usare un filo al Ni-Cr da un metro. Gli aumenti di temperatura vanno da 1 °C a 3°C al minuto in 20 mL di acqua, a seconda del tipo di batteria e del suo stato di carica. Per il calcolo, come al solito, si moltiplicano i mL d’acqua per l’aumento di temperatura, ricavandone le calorie. Moltiplicando per 4,2 si hanno i joule che, divisi per i secondi trascorsi, danno la potenza della pila in watt, cioè in joule al secondo. La potenza erogata da una batteria da 4,5 V, per tempi superiori al minuto, è di 1,5-3 watt.
14. Quanta energia è contenuta in una noce?
L’esperienza dovrebbe essere preceduta da un esame dei valori energetici riportati nelle confezioni. Da essi si può ricavare il fattore 4,2 per la conversione da calorie a joule e l’informazione che i grassi (contenuti nella noce per circa il 40%) sono capaci di liberare più energia, al grammo, degli altri principi alimentari.
Si parte da un quarto di gheriglio di noce infilzato su di un sostegno ricavato da un fermaglio, del quale si piega un’estremità verso l’alto, in modo che la parte restante funga da base. Occorre poi un barattolo di latta senza fondo, alla base del quale siano stati fatti dei fori (dall’esterno verso l’interno) dai quali dovrà entrare l’aria e in cima al quale si saranno ricavati dei tagli verticali di circa un centimetro e a intervalli di circa un centimetro, lungo tutto il diametro. Si formeranno così delle lamelle, lungo il bordo in alto del barattolo, che saranno tutte piegate verso l’esterno di circa 45 °. Dalle aperture delle lamelle dovranno uscire i fumi della combustione. Se questo non dovesse accadere la fiamma si spegnerebbe. Occorre infine una casseruola di alluminio con la base abbastanza larga da poter essere poggiata sul barattolo, contenente una ben precisa quantità d’acqua (100 mL) e un termometro. Le operazioni da eseguire sono le seguenti:
Dall’aumento di temperatura moltiplicanto per 100 g e per 4,2 J/g, si ricava l’energia in joule prodotta dalla noce. Tale energia è identica a quella disponibile per l’organismo se si assume la stessa noce come alimento. La parte restante del gheriglio può essere usata per ripetere l’esperienza, anche con diverse quantità d’acqua (cambierebbe il calore trasferito con una diversa quantità d’acqua?) e per mostrare come esso contenga un materiale oleoso, semplicemente appoggiandola su un foglio di carta (l’apporto nutritivo della noce deriva prevalentemente da lipidi, zuccheri o proteine?)
L’esperimento costituisce un’ottima occasione per affrontare problemi relativi al calcolo, alle trasformazioni dell’energia, all’alimentazione, ma non può essere considerato un metodo valido per determinare il potere calorico della noce o dell’olio in essa contenuto, a causa delle perdite di energia nei fumi e dalla bacinella verso l’aria esterna. Per limitare la perdita si può coprire la casseruola con un piano di polistirolo che, con un foro al centro, può anche fungere da sostegno del termometro, oppure aumentare la quantità d’acqua (2 decilitri) che così si troverà a temperatura non molto più alta dell’ambiente esterno.
15. Se si riscaldano nello stesso modo quantità identiche di acqua e di olio, la temperatura dei due salirà ugualmente?
La risposta è no. Per scoprirlo si possono utilizzare due lattine contenenti rispettivamente 250 g di acqua e 250 g di olio, poste sulla piastra di un fornello elettrico, ciascuna con un termometro immerso nella parte centrale del liquido. Se si registrano i valori di temperatura a intervalli regolari di tempo si potrà constatare che la temperatura dell’acqua si mantiene più bassa, anche se il calore che attraversa le lattine e la temperatura della piastra su si cui sono appoggiate sono identiche.
In questo caso si sono misurate sia la temperatura interna che quella esterna. Il termometro interno è tenuto sospeso da una molletta metallica. La stessa lattina è stata usata sia per l’acqua che per l’olio. Con un fornello di maggiori dimensioni le due lattine potrebbero essere posizionate e riscaldate in parallelo.
L’acqua subisce un minore incremento di temperatura, poiché possiede una maggiore capacità termica dell’olio, cioè richiede una quantità maggiore di calore per incrementare di un grado la sua temperatura. La capacità termica specifica dell’acqua è di 4,2 joule/°C, quella dell’olio di vasellina, usato in questo esperimento, è circa 2,1 joule/°C (olio d’oliva 2,0 J/°C, olio di semi 1,7 J/°C)
Questa sezione contiene le descrizioni di alcune esperienze proposte dai tutor riguardanti i concetti presentati nel percorso descritto per le varie classi della scuola elementare.
L’obiettivo è di fornire una documentazione descrittiva e visiva degli “oggetti didattici” previsti dal progetto.
Le esperienze descritte hanno alcune caratteristiche comuni: uso di materiali poveri e di facile reperibilità, individuazione dei concetti scientifici o pro-scientifici su cui lavorare, documentazione visiva (fotografie, video, disegni).

Una bolla di sapone può “galleggiare” immobile all’interno di un barattolo, grazie a un trucco: il barattolo è pieno di anidride carbonica.
Si può decidere dall’inizio se portare un barattolo già pieno di anidride carbonica e ben sigillato (magic science) o se mostrare tutta la preparazione. Con i bambini della classe quinta di Sambucheto, nella primavera 2003, abbiamo optato per la seconda soluzione. Alla fine essi stessi hanno spiegato tutti i fenomeni osservati e ripetuto l’esperimento da soli per mostrarlo alle altre classi.

Predisporre i materiali come nella foto. Meglio mettere all’inizio un’abbondante riserva di bicarbonato. Da notare che nel tubo di gomma ci sono due batuffoli di ovatta infilati alle estremità, per evitare che l’areosol (che si forma quando si mette l’aceto sul bicarbonato) entri appannando e bagnando il fondo del barattolo. Per evitare che a causa delle correnti d’aria l’anidride carbonica esca dal barattolo conviene chiuderlo con un cartoncino forato per far passare il tubo o con lo stesso tappo a vite spostato leggermente (infatti l’anidride carbonica tende a rimanere in basso, come se fosse un liquido, anche se il tappo è aperto).

L’aceto va versato poco per volta, senza agitare. Quindi si preme il tubo nel collo dell’imbuto e si agita gradualmente, in modo da controllare la schiuma ed evitare che vada a finire nel tubo. Il gas attraverserà l’ovatta ed entrerà nel barattolo, stratificandosi dal basso e scacciando l’aria dalla sommità.
Dopo 4 o 5 immissioni (si tenga presente che ogni decilitro di aceto origina circa un litro di anidride carbonica, considerate le perdite, e consuma 4 g di bicarbonato) si può iniziare a vedere se il barattolo è pieno, infilando dall’alto un fiammifero acceso.

Se questo si spegne all’istante vuol dire che il barattolo è pieno e lo si può chiudere. Ovviamente disponendo di una bombola di anidride carbonica compressa o di un estintore aperto ad anidride carbonica, l’operazione di riempimento sarebbe molto più agevole.

Per preparare la saponata per le bolle, sciogliere un cucchiaio di zucchero in 4 cucchiai di acqua distillata calda, aggiungere a caldo un volume uguale di detersivo liquido per piatti e agitare a lungo con il cucchiaio. Chiudere in un barattolino per l’uso successivo.
Con una cannuccia provare a formare le bolle di 6-8 cm di diametro e a staccarle, operazione che dovrà essere effettuata sull’imboccatura del barattolo una volta aperto. Aprire il barattolo svitando il coperchio e facendolo poi scorrere orizzontalmente e lentamente, per evitare rimescolamenti eccessivi con l'aria soprastante..
.
Il metodo migliore è di soffiare le bolle con la cannuccia immersa nel barattolo. Quando saranno abbastanza grandi saliranno da sole ancor prima di staccarsi dalla cannuccia. Se si staccano bolle troppo piccole queste cadranno sul fondo.

Se il barattolo è ben pieno di gas la bolla galleggerà in cima alla sua superficie. Appena scende un po’ al disotto dell’orlo si può chiuderla nel barattolo. La bolla è intrappolata!

La bolla contiene aria, un gas più leggero dell’anidride carbonica*.
Stranamente la bolla non è immobile: nei tempi lunghi si nota che tende a scendere. Questo fatto si spiega con il modello particellare e sapendo che l’anidride carbonica si scioglie in acqua.
Le sue particelle si sciolgono prima nella pellicola liquida della bolla e da qui rievaporano anche all’interno. Il risultato è che, a poco a poco, la bolla si riempe di anidride e diventa sempre più pesante. L’aria invece non si scioglie molto nell’acqua e non riesce a uscire dalla bolla… finché…
Ci sono dei giochi che consentono di creare bolle colorate con sottilissimi film di plastica. Magari in questo modo si possono creare delle bolle che galleggiano per sempre! Chi ci prova?
* Nota dell'autore: Alcuni bambini hanno detto che sapevano la formula dell’anidride carbonica (CO2) e che nell’aria c’era ossigeno. Perciò, hanno detto, “per forza l’anidride carbonica ha particelle più pesanti dell’aria (CO2>O2)”. Da quel momento ho smesso di fare acrobazie per semplificare la spiegazione. Ma non è detto che vada sempre così bene. Una cosa è non spiegare la chimica alle elementari, un’altra è darsi la zappa sui piedi e decidere di non utilizzare vantaggiosamente i concetti che i bambini hanno acquisito da altre “agenzie formative”, soprattutto i genitori. Anzi, a scuola tutte le esperienze dei bambini andrebbero catturate sistematicamente, socializzate e capitalizzate in modo ordinato.
Questa esperienza è stata ideata e descritta da Alfredo Tifi
Si dice spesso che i materiali metallici sono conduttori di calore.
Questo esperimento mette in evidenza che i “buoni conduttori” di calore non sono, in realtà, tutti ugualmente “buoni”. Insomma abbiamo a che fare con una proprietà che varia, e non poco, a seconda del metallo.
Guarda il video dell'esperimento
La tabella riporta i valori della conducibilità termica di diversi metalli.
|
Metallo Conducibilità/W/(cm·°C) |
![]() |
I dati qui raccolti sono in sintonia con i risultati dell’esperimento, in quanto l’acciaio ha minore conducibilità e l’alluminio è un miglior conduttore rispetto all'ottone e all’acciaio. Il rame è nettamente superiore anche all’alluminio nel trasporto di calore e nell’esperimento con una barra di rame si dovrebbe vedere la differenza.
Il materiale con la maggiore conducibilità termica è il diamante: il suo valore di conducibilità può andare da 9 a 26 delle unità in tabella, cosa che lo rende estremamente freddo al tocco. Tra i metalli, la lega al 72% di argento e il 28% di rame (CuSil) conduce meglio il calore rispetto al solo argento.
Le seguenti immagini sono tratte dal sito www.hometrainingtools.com
Le quattro barrette oblique sono di ottone, rame, alluminio e acciaio. Alle estremità ci sono dei piccoli fori su cui far aderire le gocce di cera fusa.



Si pongono 4 gocce uguali di acqua colorata a distanze regolari e una quinta all’estremità delle barrette. Si accende il fornellino, che in pochi minuti supera la temperatura di 200 °C. Le gocce bolliranno quando la temperatura supererà i 100 gradi a causa della trasmissione del calore. Può essere opportuno mettere le gocce più distanti solo dopo che le vicine siano evaporate.
Questi i risultati del nostro esperimento:
12:09 - accensione
12:12 - 1ª bolla alluminio (Al)
12:13 - 1ª bolla ottone (Ot)
12:14 - 2ª bolla Al
12:16 - 1ª bolla acciaio (Ac)
12:17 - 2ª bolla Ot
12:17 - 3ª bolla Al
12:20 - 3ª bolla Ot
12:28 - 4ª bolla Al
12:30 - 5ª bolla Al
12:30 - inizia la 2ª bolla Ac e la 4ª bolla Ot; si altera la scritta dell’alluminio.
Esperienza realizzata da Luciano Mancinelli
Il modo più semplice per vedere l'ossigeno prodotto dalle foglie è di fare come in queste foto. Le foglie, sia quella esposta al sole, sia quella tenuta al buio, sono immerse in acqua di rubinetto. L'esperienza è durata appena mezz'ora... e i risultati si vedono!

Esperimento avviato: una foglia si trova esposta alla luce del sole, l'altra al buio

Dopo mezz'ora confrontiamo i risultati

La foglia esposta ai raggi del sole si è ricoperta di bollicine

La foglia rimasta al buio non ha nessuna bollicina
Questa esperienza è stata ideata e descritta da Alfredo Tifi
Il Nitinol è una lega di nichel e titanio al 50% circa, scoperta per caso dal Naval Ordnance Laboratory circa 40 anni fa e caratterizzata dalla memoria di forma.
Da un filo di questa lega si può ricavare una forma, come per qualsiasi fil di ferro. La forma viene “fissata” mantenendo il filo a 500–550°C e raffreddandolo.
Ma a differenza di un normale filo d’acciaio, una volta distrutta la forma per stiramento, immergendolo in acqua calda o scaldandolo con un phon esso recupera repentinamente il motivo iniziale.

Il filo in figura riproduce la scritta ICE (Institute for Chemical Education)

Francesca stira il filo fino a farlo diventare completamente diritto…

Ma basta immergerlo in acqua calda perché esso recuperi istantaneamente la forma iniziale.
Il nitinol può esistere in due fasi, chiamate austenite (stabile a caldo) e martensite (stabile a freddo), con la stessa forma.
La deformazione a freddo provoca lo slittamento di regioni microscopiche di martensite l’una sull’altra, coinvolgendo distorsioni solo nelle zone di confine tra un dominio e l’atro. L’aumento di temperatura provoca il passaggio alla fase austenitica.
A causa della maggiore agitazione termica, le zone di tensione recuperano, a caldo, le posizioni originarie, stabili anche una volta raffreddato il filo alla temperatura ambiente e riportato alla fase martensite.
Esperienza proposta da Alfredo Tifi
Si tratta di una esperienza sui concetti di baricentro e di stabilità dell'equilibrio.
Nella semplice operazione di attaccare un quadro a una parete ricerchiamo in maniera intuitiva una soluzione che renda l’equilibrio stabile.
Se riflettiamo sulle operazioni che facciamo nell’attaccare un quadro possiamo spiegarci la “stranezza” del video che viene presentato in fondo a questa pagina.

Materiale

Procedimento
Conficcare lo stuzzicadenti nella zona centrale di una delle basi del tappo

Conficcare le forchette nel sughero in modo più o meno simmetrico.
Abbiamo realizzato il nostro equilibrista.
Guarda il video dell'esperienza
Esperienza proposta da Natale


Quando il barattolo è inclinato verso l'alto, le monete non premono sul tappo e il sommergibile è in emersione.
Basta appoggiare il tappo sulle monete e premere per avere l'immersione; a causa della contrazione della piccola camera d'aria, il sommergibile scende e sale.
Guarda il video dell'esperienza
Esperienza proposta da Luciano Mancinelli
Si tratta di una esperienza sul concetto di interazione a distanza.
Materiali
Procedura



Si tratta di un'esperienza sulla diversa densità dei materiali.
Il becker A contiene alcol: immergendo un piccolo palloncino con ghiaccio all’interno, queto si posiziona sul fondo.
Il becker B contiene acqua: immergendo un analogo palloncino, questo galleggia.

Mescolando i contenuti dei due becker, in quale posizione si vengono a trovare alcol, acqua e ghiaccio?
Qual è il più denso dei tre materiali?
Qual è il meno denso?


Esperienza proposta da Luciano Mancinelli
Per raffreddare i corpi il miglior sistema è quello di immergerli in acqua: un ferro rovente immerso in acqua cede quasi istantaneamente la quantità di calore in eccesso. Questa proprietà dell’acqua è la chiave per capire come mai il palloncino contenente acqua, messo a contatto con la fiamma della candela, non esplode.
Guarda il video dell'esperienza
Sarebbe auspicabile realizzare l’esperienza con un palloncino gonfiato solo con aria e uno contenente acqua.
Ulteriore esperienza proposta
Due lattine contengono una acqua e l'altra olio. Come si fa a scoprire, con una piastra riscaldante, quale contiene acqua e quale olio?
Il problema può essere risolto mettendo le due lattine sulla stessa piastra e vedendo quale si riscalda più lentamente.
Tre palloncini sono riempiti con quantità di acqua diverse: quello bianco ne contiene una picccola quantità, quello arancione una quantità intermedia, quello giallo una quantità maggiore.
Inizialmente i palloncini sono immersi in acqua fredda (a 15 °C).
Guarda il video dell'esperienza
I tre palloncini vengono tolti dall'acqua a 15° e immersi nell'acqua a 45°. Tutti e tre vanno a fondo.
Il palloncino bianco, all'estrema destra, sale piuttosto rapidamente.
Poi comincia a salire anche il palloncino arancione che conteneva una quantità di acqua intermedia.
Infine, anche il palloncino giallo comincia a muoversi. La temperatura dell'acqua è scesa a 40°. Dopo due minuti, il palloncino giallo (con un volume d'acqua maggiore) si è riscaldato, sta salendo e raggiunge la superficie.
Esperienza proposta da Luciano Mancinelli
Se si sottopone a una piccola vibrazione il vaso di sabbia, subito dopo il nostro “pippopopotamo” inizia a sprofondare. Ha forse mangiato troppo? In effetti, guardandolo bene all’interno, si troverebbe che è imbottito di pallini di piombo. Ma questo non basta a spiegare la magia. Un suggerimento: tenete d’occhio il livello della sabbia!

L’esperimento fa uso di un semplice imbuto, chiuso da una pila a stilo, infilata dall’interno e cementata da un po’ di sabbia umida lasciata seccare, come illustrato dalla seguente sequenza di immagini.

La pila è infilata senza forzarla nell'imbuto...

... e tenuta bloccata da un po' di sabbia bagnata

Si adagia l'imbuto sul fondo del barattolo...

... e si copre di sabbia fino alla sommità.
Imprimendo una piccola vibrazione al barattolo, si provoca il distacco della sabbia che sostiene la pila, la quale cade nello spazio vuoto dell’imbuto che, in alcuni secondi, si riempie della sabbia soprastante, trascinando con sé il pesante animale.
Il fenomeno di rottura della crosta sabbiosa, a causa di uno spazio vuoto sottostante, si chiama subsidenza, ed è abbastanza frequente nei deserti. A causa dei venti che soffiano la sabbia in una direzione costante, si creano delle cornici di crosta sabbiosa che sovrastano grosse bolle d’aria e che sono instabili. Le jeep o i dromedari rischiano di essere inghiottite allo stesso modo del nostro “pippopopotamo”. Il fenomeno può anche avere origini non naturali, quando la bolla d’aria è causata dall’estrazione del petrolio o dal pompaggio di acqua sotterranea.
Guarda il video dell'esperienza
Esperienza realizzata da Luciano Mancinelli
Questa esperienza rappresenta una unità didattica completa, che presenta alcuni esempi di possibili cambiamenti nella struttura degli aggregati di atomi che si verificano nelle trasformazioni chimiche e costituisce un supporto per rendere trasferibile e ripetibile l’esperienza, nell’ambito di un percorso più completo sulla struttura della materia, che parte dal modello particellare.
Nozioni di base riguardo a:
Una sostanza corrisponde a un aggregato di atomi. Negli elementi gli aggregati contengono solo atomi dello stesso tipo.
![]() |
![]() |
![]() |
| a) Elemento con atomi non aggregati | b) elemento con atomi associati a coppie | c) elemento con atomi aggregati in una struttura compatta |
Nei composti ci sono invece ripetizioni regolari di abbinamenti tra atomi diversi.
![]() |
![]() |
![]() |
| a) Aggregazioni di due atomi diversi formano le molecole di un composto AB | Un composto AB formato da due elementi diversi dal precedente] | c) Composto formato da un aggregato compatto di atomi disposti regolarmente |
![]() |
![]() |
![]() |
| d) Molecole uguali di un composto AB2 | d) Aggregazione solida degli atomi in un composto di tre elementi | e) altro composto solido formato da atomi di due elementi |
In ogni caso, se gli atomi si uniscono a formare gruppetti separati l’uno dall’altro, tali aggregati si chiamano molecole. È importante precisare non solo quali atomi formano le molecole, ma anche come sono disposti. Le molecole di destra nell'immagine qui sotto sono diverse da quelle di sinistra, e le corrispondenti sostanze avranno proprietà diverse.

Se si modificano il numero e la disposizione degli atomi negli aggregati, cioè se si modifica il loro modo di stare uniti, cambiano tutte le proprietà della sostanza, comprese quelle che possiamo vedere con i nostri occhi.
Una sostanza ha numerose proprietà. La seguente tabella mostra le proprietà di due composti: l’acido acetico (principale componente dell’aceto) e il bicarbonato di sodio.
| Proprietà | Acido acetico | Bicarbonato di sodio |
| Stato fisico a 20 °C | Liquido | Solido |
| Effetto del riscaldamento | Fonde a 16 °C e bolle a 118 °C | Si decompone liberando anidride carbonica a 270 °C trasformandosi in carbonato di sodio |
| Solubilità in acqua | Illimitata | 90 grammi/litro |
| Solubilità in alcol | Illimitata | Insolubile |
| Densità | 1,05 g/cm3 | 2,16 g/cm3 |
| Colore con la cartina del pH | Rosso (acido) | Blu (basico) |
| Reazione con aceto | --- | Sviluppa effervescenza |
| Reazione con bicarbonato | Sviluppa effervescenza | --- |
Le particelle singole non possiedono quasi nessuna di queste proprietà: un singolo atomo non può essere né solido né liquido né gassoso, non fonde né bolle, non si scioglie e non ha colore. Queste sono tutte proprietà che possono avere solo gli aggregati formati da molte particelle, non i singoli atomi o le singole molecole.
Le ultime tre proprietà della tabella e la capacità di decomporsi a caldo del bicarbonato sono proprietà chimiche, perché riguardano la capacità di originare nuove sostanze.
Nelle trasformazioni chimiche si modifica il modo di aggregarsi degli atomi e perciò emergono nuove sostanze, i prodotti, con proprietà completamente diverse da quelle delle sostanze iniziali, i reagenti. Le prove più comuni e visibili di queste trasformazioni sono:
Qualsiasi cambiamento delle proprietà può essere in genere associato alla comparsa o alla scomparsa di una sostanza. Fanno eccezione i passaggi di stato e la formazione di soluzioni, in cui si possono verificare cambiamenti di colore, formazione o scomparsa di solidi o gas e cambiamenti di temperatura senza che si formino nuove sostanze. In questo tipo di trasformazioni, chiamate trasformazioni fisiche, le sostanze coinvolte conservano alcune proprietà e inoltre esse possono essere recuperate nella forma iniziale, ripristinando le condizioni di temperatura e pressione iniziali o eliminando il solvente se erano state sciolte.
Ma cos’è che provoca le trasformazioni chimiche? Ovvero, perché semplicemente associando due sostanze, o somministrando energia a una sola sostanza, si innesca la formazione di nuove sostanze?
Il modello particellare fornisce due indizi per rispondere a questa domanda. Secondo tale modello le particelle sono soggette a un movimento tanto più frenetico quanto maggiore è la temperatura. Il semplice riscaldamento di una sostanza può quindi provocare la frammentazione in aggregati più piccoli. Il modello particellare prevede inoltre che le particelle e gli atomi si attraggano, cioè abbiano affinità gli uni per gli altri. L’agitazione termica garantisce una certa libertà, agli atomi degli aggregati, di staccarsi parzialmente per “esplorare” nuove combinazioni, alcune delle quali daranno attrazioni più forti. Si può dire che un sistema chimico somiglia ad una sala da ballo, dove entrano molte coppie che possono sperimentare nuovi partner, e dalla quale escono coppie diverse e più “affiatate”. Vediamo ora il comportamento di alcuni sistemi chimici.
Introdurre nel recipiente circa 1 g di zinco, circa 5 mL di acqua e infine circa 1 g di iodio solido. Se non si dispone di questo è possibile sostituire l’acqua con la tintura di iodio. Aggiungere qualche goccia di aceto. Chiudere la provetta ed agitare a lungo.
Se si parte da zinco solido, il liquido prima diventerà più scuro, divenendo simile alla tintura di iodio. Lo iodio in soluzione reagirà più rapidamente con lo zinco e dopo circa 5 minuti si osserverà una rapida decolorazione, fino a un colore giallo chiaro.
La soluzione può essere travasata in un becher, lasciando l’eccesso di zinco nella provetta, e fatta evaporare su una piastra termica fino a isolare il prodotto dell’unione dei due elementi, cioè il composto ioduro di zinco.
| Il fenomeno in concreto | Il modello |
|
|
|
| Con l’evaporazione dell’acqua le particelle del composto di iodio e zinco possono aggregarsi e formare un solido. A destra modello di ioduro di zinco solido. | ![]() |
Altri sistemi chimici che seguono lo stesso modello sono, per esempio, la combustione del magnesio e la formazione della ruggine.
Sciogliere due cucchiaini rasi di cloruro di rame in mezzo bicchiere di acqua distillata, per avere una soluzione limpida. Introdurre nella soluzione una lastrina di alluminio, ottenuta ritagliandola da una casseruola in tale materiale. Da notare che il foglio di alluminio per avvolgere gli alimenti è troppo sottile e si disgrega completamente, quindi l’eccesso di tale elemento non può essere separato facilmente a fine reazione.
Osservare tutti i fenomeni che accompagnano la trasformazione. In questa trasformazione un elemento ne sostituisce un altro combinato in un composto, producendo un nuovo composto e un altro elemento.
Una reazione secondaria, dello stesso tipo, interessa l’alluminio (elemento) e l’acqua (composta da idrogeno e ossigeno): l’alluminio sostituisce l’idrogeno e si combina con l’ossigeno. L’idrogeno, rimasto senza “partner”, si libera sotto forma di bollicine.
![]() |
![]() |
![]() |
|
| Chiave: bianco = alluminio, giallo = cloro; rosso = rame. | |
In una bottiglietta introdurre metà volume di acqua ossigenata (perossido di idrogeno) al 3%. Si può notare che da tale soluzione si liberano alcune bollicine (il disinfettante scade e perde di efficacia dopo uno o due anni). Aggiungere poi un cucchiaino di polvere nera di biossido di manganese. Chiudere subito il collo della bottiglia con un palloncino di gomma e agitare.
Il gas prodotto farà gonfiare il palloncino. Facendo uscire un po’ di tale gas e dirigendolo su un pezzetto di legno incandescente appena spento, si ravviverà la combustione. La capacità di ravvivare la combustione è una proprietà dell’ossigeno, prodotto dalla decomposizione dell’acqua ossigenata.
Il biossido di manganese ha solo la funzione di accelerare la decomposizione dell’acqua ossigenata, che si verifica anche spontaneamente. Il biossido di manganese non si trasforma in altre sostanze, infatti, una volta terminata l’effervescenza, si può recuperarlo e utilizzarlo quante volte si desidera con altra acqua ossigenata.
In questa reazione accade che un composto si suddivide in un composto più semplice e in un elemento.
| Il fenomeno in concreto | Il modello |
![]() |
acqua ossigenata
acqua + ossigeno |
In genere le reazioni di decomposizione sono provocate dalla somministrazione di energia (termica, elettrica, luminosa) come nel caso della decomposizione dello ioduro di zinco.
Sciogliere in un becher o in una piastra di Petri lo ioduro di zinco ottenuto dalla reazione tra iodio e zinco, o usare direttamente la soluzione di questo composto ottenuta nell’esperienza sopra descritta. Immergervi due lamine di rame collegate al polo positivo e negativo di una batteria da 9 V.
Al polo positivo si formerà la colorazione bruno-rossiccia dello iodio, al polo negativo si formeranno dei cristalli lucenti metallici e grigi, di zinco. Quindi gli stessi due elementi possono essere uniti in un composto e poi separati fornendo energia.
| Il fenomeno in concreto | Il modello |
|
Dalla soluzione del composto si rigenerano gli elementi iodio (al polo positivo, rosso) e zinco metallico (al polo negativo, nero). |
|
In una bottiglietta introdurre due cucchiai di bicarbonato di sodio, versarvi aceto senza superare la metà del volume e chiudere subito con il palloncino di gomma. Il gas prodotto lo gonfierà.
Quando la reazione è terminata il liquido non conterrà più acido acetico. Senza far sgonfiare il palloncino scaricare il liquido e verificare con la cartina indicatrice che esso non è più acido come l’aceto iniziale. Aggiungere altro aceto e richiudere con lo stesso palloncino, che si gonfierà ulteriormente del gas sviluppato (anidride carbonica). Il liquido ottenuto, separato dal bicarbonato in eccesso, può essere evaporato. Si otterrà una sostanza che non ha più la capacità di dare effervescenza con acido acetico: l’acetato di sodio.
In questa reazione da due composti si originano altri due composti. Fanno parte di questa categoria tante altre reazioni, come quella tra cloruro rameico e idrossido di sodio, in cui si forma cloruro di sodio (sale da cucina) e idrossido rameico, un solido blu insolubile in acqua.
| Il fenomeno in concreto | Il modello |
![]() |
|
| L’anidride carbonica ha formula CO2 e nel modello dei prodotti la sua molecola corrisponde al mattoncino nero con due rossi. Il bicarbonato di sodio, formato da quattro elementi, ha struttura più complessa. | |
Questo composto rosso vivo, se riscaldato sopra i 130 °C, subisce un riarrangiamento interno dei suoi atomi.
Alla nuova disposizione corrisponde una evidente diversa proprietà: il colore che diviene giallo. A temperatura ambiente si rigenera l’aggregazione atomica originaria e il colore torna rosso.
Lo ioduro di mercurio è ottenibile per combinazione diretta degli elementi iodio e mercurio.
| Il fenomeno in concreto | Il modello |
|
Composto HgI2 in condizioni normali, a temp. ambiente |
![]() |
|
Riscaldandolo a più di 127 °C si modifica il modo di stare insieme dei suoi atomi e cambiano le sue proprietà, compreso il colore e la densità (5% meno denso) |
![]() |
|
A temperatura ambiente, a poco a poco, si ripristina l’arrangiamento iniziale, più compatto. A destra il modello presenta alcune zone compatte e altre che devono ancora riarrangiarsi |
![]() |
Tutte le reazioni chimiche descritte, tranne l’ultima, sono state realizzate dal tutor Alfredo Tifi presso la seconda media dell’Istituto Comprensivo di Appignano il 28 maggio 2004, con l’insegnante Valeria Bellucci.
Questa sezione contiene le descrizioni delle esperienze realizzate dagli insegnanti e dagli allievi delle scuole elementari che hanno partecipato al progetto didattico proposto.
Le esperienze descritte hanno alcune caratteristiche comuni: uso di materiali poveri e di facile reperibilità, individuazione dei concetti scientifici o pro-scientifici su cui lavorare, documentazione visiva (fotografie, video, disegni).
Le due classi riunite di 41 allievi sono state divise in 4 gruppi (A, B, C, D), con il compito di studiare l'aria sulla base di un percorso tracciato attraverso delle schede guidate.
Per le fasi sperimentali del lavoro (pomeridiano) sono stati impiegati 3 pomeriggi da due ore l'uno, a distanza di diverse settimane tra una unità e l'altra. Per la realizzazione dei test, delle riflessioni e delle verbalizzazioni necessarie, le insegnanti di scienze, nelle proprie classi, hanno utilizzato altro tempo.
1° GIORNO
Dalla beuta è stata tolta metà dell’aria. Ovviamente non è possibile vedere l’aria, ma si può sentire, ad esempio, il soffio che essa produce rientrando nella beuta.
Immaginiamo ugualmente di possedere degli occhiali “magici” che consentano di vedere l’aria e di ingrandirla. Se questa è la situazione prima di aspirare, quale parte della beuta rimane senza aria?

L'esperimento è stato condotto con una campana di vetro e pompa a vuoto manuale. Le discussioni di gruppo hanno prodotto questi disegni e descrizioni.
![]() |
| Gruppo A: L'aria occupa tutto lo spazio a disposizione |
![]() |
| Gruppo B: 1. aria spinta da forze di coesione; 2. agitazione termica, cioè l'aria è sparsa |
![]() |
| Gruppo B1: 1. L'aria è molto stretta, molto compressa, in quanto è parecchia (molta forza di coesione); 2. L'aria non è presente completamente, ma solo in modo parziale. L'aria è in movimento in quanto è poca (poca forza di coesione) |
![]() |
| Gruppo B2 |
![]() |
| Gruppo C |
![]() |
| Gruppo D1 |
![]() |
| Gruppo D2: 1. L'aria è distribuita regolarmente; 2. L'aria è rimasta ai lati |
![]() |
| Gruppo D3 |
L'ipotesi del gruppo A rispecchia la situazione macroscopica. I suoi punti deboli sono che non risponde alla domanda "dove manca l'aria", ma tiene conto del fatto che l'aria tende sempre a occupare tutto il volume a disposizione.
Le ipotesi del gruppo B sono accomunate dal fatto che l'aria residua lascia dei vuoti localizzati, in certa misura dispersi. I domini in cui è suddivisa l'aria residua sono immaginati cangianti in forma e mobili. Un punto debole dell'ipotesi, che comunque spiega dove manca l'aria, è che restano intere regioni senza aria. Si noti che le conoscenze puramente scolastiche pregresse, sulle forze di coesione e sull'agitazione termica, sono completamente inutili nel fornire una rappresentazione corretta dell'aria, poiché esse non sono state né costruite né integrate autonomamente in una rete concettuale coerente e significativa. La forza di coesione è associata al grado di compattezza dell'aria anziché a una forza interna. Questa errata concezione dovrà essere corretta.
L'ipotesi del gruppo C è sostanzialmente corpuscolare. I punti di forza sono che l'aria occupa tutte le regioni dello spazio e nello stesso tempo si riconoscono gli spazi vuoti.
Le ipotesi del gruppo D localizzano l'aria residua in una parte del recipiente. In basso D1 ed esternamente gli altri due gruppi. Non sono date giustificazioni per queste ipotesi, anche se la D1 può essere sostenuta dal fatto che l'aria residua ha un peso; oppure il fatto che si concentri in basso spiega la difficoltà a sollevare la cupola di vetro.
Rispondere alle seguenti domande:
a. Come fa l’aria che si trova in fondo alla siringa ad accogliere altra aria, quando premiamo il pistone?



b. Quale ipotesi disegnata nelle beute spiega meglio come si possa comprimere l’aria?
c. Che cosa ha di speciale la struttura dell’aria che ne permette la compressione?
Rispondere alle seguenti domande:
d. Nell'aria è maggiore lo spazio vuoto o lo spazio occupato dalle particelle?
e. Perché non si può raggiungere un volume nullo anche comprimendo con una forza tremenda?
2° GIORNO
f. Come fa il profumo a raggiungere il naso?
Si sono avute 2 risposte per l'opzione 1 e 5 risposte per l'opzione 2.
g. Come fa l’ammoniaca a muoversi se il tubo è chiuso e pieno d’aria?
Si sono avute 3 risposte per l'opzione 2, 1 risposta per l'opzione 3 e 5 risposte per l'opzione 4; 2 gruppi hanno dato 2 risposte.
h. Il pistone si mette in moto perché:
Si sono avute 1 risposta per l'opzione 3, 7 risposte per l'opzione 4; 1 gruppo ha dato 2 risposte.
i. Quali aggiunte bisogna fare al modello di gas finora ricavato (particelle e spazio vuoto)?
C'è stata 1 risposta: bisogna aggiungere il movimento delle particelle.
7° Dimostrazione: un palloncino di gomma chiuso con poca aria viene introdotto nella beuta, e da questa si aspira l’aria.
j. Cosa accadrà al palloncino?
Si sono avute 3 risposte per l'opzione 1, 2 risposte per l'opzione 3; 2 gruppi non hanno risposto.
| Disegna gli ingrandimenti prima e dopo l’aspirazione dell’aria | La dimostrazione è stata realmente effettuata col seguente risultato | |
![]() Nessun disegno |
![]() prima |
![]() dopo (vuoto) |
k. Perché non si formano bolle d’aria lasciando la bottiglia da sola?
l. Qual è l’effetto della temperatura sull’aria e sulle sue particelle?
Non è stata data alcuna risposta a queste domande.
3° GIORNO
m. Come si origina l’odore?
3 gruppi hanno scelto l'opzione 3, 1 gruppo ha scelto le risposte 2 e 3.
n. Come si può estendere ai solidi e ai liquidi il modello particellare?
o. Cosa tiene unite le particelle nei liquidi e nei solidi?
p. Come spiega il modello particellare il fatto che il colorante si diffonde più velocemente nell’acqua calda?
Un gruppo ha scelto la risposta 4; 3 gruppi hanno scelto la risposta 3.
q. Perché, secondo il modello particellare, le due gocce si sono unite?
3 gruppi hanno scelto la risposta 2; 1 gruppo ha scelto la risposta 4.
r. C’è un ultimo tassello da aggiungere al modello particellare per completare il quadro della materia solida e liquida (stati condensati). Quale?
3 gruppi hanno risposto: forze di coesione; 1 gruppo non ha risposto.
s. Cosa succede all’alcol mentre si raffredda (due risposte esatte)?
Si sono avute 3 risposte per l'opzione 1, 1 risposta per l'opzione 2, 4 risposte per l'opzione 4; 1 gruppo ha dato una sola risposta.
t. Cosa succede alle particelle dell’alcol mentre scompare dalla mano?
Si sono avute 2 risposte per l'opzione 1, 2 risposte per l'opzione 2, 1 risposta per l'opzione 3; 1 gruppo ha dato 2 risposte.
u. In base al modello particellare, perché l’alcol evapora?
Si sono avute 2 risposte per l'opzione 1, 2 risposte per l'opzione 2.
v. I cristalli di antitarme col tempo si rimpiccioliscono. A sinistra delle frecce c'è un piccolissimo cristallo fatto da poche particelle. Quale disegno, tra A, B e C, spiega meglio la riduzione delle dimensioni del cristallo?

Non è stata data alcuna risposta.
Per ogni fenomeno, riconoscere la spiegazione data dal modello particellare (risposte corrette in corsivo)
1. Alla luce del modello particellare dell’aria, perché un pallone gonfiato d’aria diventa duro?
Risultati: 10 risposte per l'opzione 1; 4 per l'opzione 2; 3 per l'opzione 3 e 24 per l'opzione 4.
2. Un pallone viene forato da un chiodo e si sgonfia. Qual è la spiegazione data dal modello particellare?
Risultati: 12 risposte per l'opzione 1; 4 per l'opzione 2; 4 per l'opzione 3 e 20 per l'opzione 4.
3. Quando si aspira il succo di frutta da una busta di cartone, questa si schiaccia. Lo stesso non succede se il foro è più largo della cannuccia. Come si spiega il fenomeno in base al modello particellare?
Risultati: 7 risposte per l'opzione 1; 20 per l'opzione 2; 0 per l'opzione 3 14 per l'opzione 4.
4. Cosa succede se si cerca di aspirare la bibita da un recipiente rigido (bottiglia di vetro), se la cannuccia aderisce perfettamente al foro sul tappo?
Risultati: 8 risposte per l'opzione 1; 7 per l'opzione 2; 12 per l'opzione 3 e 13 per l'opzione 4.
5. Copia nel cerchio vuoto l’ingrandimento che ritieni più verosimile per una piccola porzione d’aria compressa, secondo il modello particellare.

La risposta corretta è la D.
Risultati: 19 risposte per l'opzione A; 0 per la B; 2 per la C e 18 per la D.
Riepilogo delle risposte al questionario finale (in verde le risposte corrette; in rosso quelle errate ma scelte da molti allievi)
| Totale alunni = 41 | 1 | 2 | 3 | 4 | nessuna risposta |
| Domanda 1 | 10 | 4 | 3 | 24 | |
| Domanda 2 | 12 | 4 | 4 | 20 | 1 |
| Domanda 3 | 7 | 20 | 14 | ||
| Domanda 4 | 8 | 7 | 12 | 13 | 1 |
| Domanda 5 | 19 | 2 | 18 | 2 |
Conclusioni delle insegnanti
Dall’analisi delle risposte, risulta che il concetto di pressione non è stato ben assimilato e che gli alunni, come era prevedibile, non hanno ancora raggiunto una capacità di astrazione sufficiente a spiegare i fenomeni naturali applicando il modello. E’ possibile ripartire da tali considerazioni per sviluppare le future attività del progetto.
Osservazioni in itinere e conclusioni del tutor
Difficoltà riscontrate:
Gli allievi presentano resistenze nell’usare il modello particellare per spiegare i fenomeni e i fatti sperimentali. Queste resistenze sono in parte fisiologiche per l’età, ma anche dovute alle difficoltà sopra citate.
Gli allievi tendono ad attribuire caratteristiche del mondo macroscopico alle particelle: sono solide le particelle dei solidi, liquide quelle dei liquidi e gassose quelle degli aeriformi. Che non si tratti di un problema linguistico è dimostrato dal fatto che diversi allievi affermano che le stesse particelle si trasformano da solide a gassose nella sublimazione, cioè attribuiscono a esse dei cambiamenti e non riescono a immaginare particelle che non siano né solide né liquide né gassose. Occorre costruire delle attività che li aiutino a pensare agli stati della materia come derivanti dal modo di stare insieme di molte particelle.
Le loro conoscenze sulle forze di coesione, precedenti all'unità didattica, hanno interferito con lo sviluppo di un concetto di pressione adeguato e basato sul moto molecolare.
Esperienza realizzata dagli allievi delle classi 1ª B e 1ª C dell'I.C. "Luca della Robbia" di Appignano (MC), nell'anno scolastico 2001-2002.
Insegnanti: Michela Rossetti, Luigina Castelli; Valeria Bellucci, al secondo anno di sperimentazione, ha seguito autonomamente un percorso parallelo nella propria classe 1ª A
Tutor: Alfredo Tifi
La classe è stata invitata a osservare il materiale che ogni coppia di bambini aveva a disposizione sui banchi singoli uniti a due a due:
I bambini dovevano provare a far accendere la lampadina con ciò che avevano a disposizione.
Alcuni bambini hanno riconosciuto nel materiale oggetti familiari perché usati per far funzionare dei giochi e uno di loro si è ricordato che una volta per far accendere un game boy, non avendo le pile giuste, ha visto fare dei “collegamenti" da altri bambini più grandi con pile diverse da quelle necessarie e fili elettrici.
Ai bambini è stato detto di fare attenzione alle “estremità” degli oggetti che hanno e soprattutto alla lampadina e alle sue parti metalliche (punta e avvitatura).
I bambini sono riusciti un po’ alla volta a far accendere la lampadina, con grande entusiasmo e, su richiesta della maestra, hanno osservato quali erano le parti venute a contatto e quante erano le coppie individuate (tre).




I bambini hanno provato diverse possibilità di contatti, variando anche il numero di materiali (per esempio 2 pile - 1 filo - 1 lampadina o 2 lampadine - 1 pila - 1 filo).
E' stato effettuato un semplice test disegnando alla lavagna varie possibilità di contatti e in una tabella le possibili interazioni e le evidenze di queste interazioni, cioè la luce o il calore.

La maestra ha disegnato le varie posizioni di pila, filo e lampadina alla lavagna; i bambini hanno cercato di prevedere se ci sarebbe stata interazione o meno.
Per ogni disposizione, due bambini sono andati davanti a tutti e hanno verificato sperimentalmente se le previsioni erano giuste o meno.
In alcune combinazioni l’interazione è evidenziata solo dal riscaldamento del filo, ma non dall’accensione della lampadina. In questo modo i bambini hanno capito che ci sono diverse evidenze per l’interazione e, in questo modo, non si identifica l’interazione con una evidenza predefinita.
Esperienza realizzata il 18-11-2004 dai bambini della classe 4° B della scuola Le Grazie di Recanati, con la maestra Pina Feliciotti
I bambini hanno svolto la seguente verifica sui concetti scientifici generali sui quali hanno lavorato durante tutto il percorso.
Collega con delle linee colorate gli esempi alle GRANDI PAROLE della scienza

Risultato del test
I bambini hanno scelto di colorare in modo diverso ciascuna parola al centro e di assegnare i colori corrispondenti ai diversi esempi che le circondano. A rotazione ogni bambino ha proposto, per ciascun esempio, la parola della scienza che secondo lui era adeguata, motivando la proposta. Gli altri bambini potevano intervenire con controproposte, alzando la mano e la discussione si interrompeva quando si raggiungeva l’accordo unanime. Il sole e l’estintore sono stati visti sia come sottosistemi che come sistemi. Il sole come facente parte del sistema solare, l’estintore come componente del sistema di sicurezza della scuola. Tutti gli altri esempi sono stati correttamente classificati senza grandi difficoltà.
Lo stesso test è stato effettuato anche in classe 3ªA a Castelnuovo, in versione semplificata (senza il concetto di modello e i relativi esempi) con analoghi risultati positivi.
Il seguente test degli specchi è un problema sulla costruzione di un modello mentale completamente diverso da quelli sperimentati durante il percorso, e ha impegnato i bambini il 30 maggio 2005.

Risultato del test
La maggior parte dei bambini ha trovato abbastanza facilmente la soluzione, mentre per altri sarebbe stato necessario sperimentare nella realtà. Alcuni percettivamente si sono rifatti alle loro esperienze, che vanno dai giochi al computer ai giochetti con la luce che si rifletteva a mensa sui coltelli.
1. Quale messaggio secondo voi ha voluto comunicarvi il tutor lavorando con noi?
2. Ma allora quale sarà stato il filo che teneva unite tutte queste cose nuove?
Sono rimasto molto soddisfatto delle riflessioni dei bambini e naturalmente del lavoro fatto da Pina durante tutto il percorso. I bambini hanno colto esattamente ciò che speravamo catturassero del processo scientifico. Sfido chiunque a ottenere lo stesso risultato seguendo il sussidiario e con lezioni esclusivamente “teoriche”. Sono convinto che questa esperienza lascerà un’impronta indelebile nella loro formazione e che sia della massima importanza che nel passaggio alla scuola secondaria sia preso in seria considerazione questo portfolio e si prosegua nella direzione di fornire strumenti cognitivi adeguati a pensare come scienziati e non a imparare a memoria piccoli pezzi di enciclopedie, nonché occasioni di affrontare ancora indagini sperimentali e ad elaborare modelli in un’ottica costruttivista. Tutto ciò nel rispetto dei bambini e con la finalità di ravvivarne spontaneità e curiosità, spirito di inquiring, contribuendo a costruire una corretta concezione della scienza e del suo ruolo per l'uomo.
Verifica di fine percorso didattico realizzata dalla maestra Pina Feliciotti e dal tutor Alfredo Tifi con i bambini della 4ªB del Plesso Le Grazie, nel maggio 2005
In questa sezione sono presentate alcune esperienze che introducono e approfondiscono il concetto di modello nella scuola elementare, attraverso lo studio di alcuni marchingegni e l'applicazione dello strumento delle macchine operatrici.
Le macchine operatrici sono degli "elaboratori" che acquisiscono dei
dati (input) e li trasformano in un risultato (output) seguendo un
algoritmo invariante e "nascosto", analogamente ai marchingegni. Ai
bambini si richiede di ideare un'operazione o una sequenza di operazioni
(modello) che riproduca il comportamento della macchina (sistema
sperimentale).
Per ora abbiamo messo delle operazioni aritmetiche
nel "motore" delle nostre macchine operatrici, che si alimentano di
numeri naturali e danno numeri naturali in uscita.
Un obiettivo
importante di queste macchine operatrici "aritmetiche" è che con esse si
può migliorare l'abilità di calcolo a mente e la comprensione delle
operazioni aritmetiche divertendosi. Per questa ragione si possono usare
le macchine operatrici fin dalla seconda elementare (limitandosi ai
livelli di difficoltà più bassi).
Ma la ragione per cui è statoscelto di utilizzare questo strumento nel percorso didattico è per applicare il concetto di modello
in situazioni più astratte.
Il "motore" delle macchine operatrici
può inizialmente essere fornito da un alunno che, alla lavagna, pensa
l'operazione o la sequenza di operazioni aritmetiche. Poi ripete invariate
tali operazioni sui dati in ingresso, forniti dai compagni di classe,
scrivendo i risultati, finché questi non saranno in grado di prevedere i
risultati.
Il parallelo con il modello scientifico è evidente: il
calcolo nascosto è il "meccanismo" o "motore sconosciuto" che produce i
fenomeni; l'input sono le condizioni e le variabili sperimentali scelte
dagli scienziati (il resto della classe); dopo pochi tentativi
(esperimenti preliminari) i bambini cercano spontaneamente un modello di
calcolo che dia conto del comportamento della macchina. Quindi ripetono
gli esperimenti per convalidare i vari modelli. Se le loro previsioni
corrispondono con l'output (risultato dell'esperimento), procedono a
ulteriori conferme.
I modelli si sforzano di riprodurre fedelmente la
realtà osservabile. Invece la realtà nascosta nella macchina, come per i marchingegni, non esce mai allo scoperto. Quando gli scienziati
ottengono previsioni corrette considerano valido il loro modello, ma
non possono mai essere definitivamente certi che la natura complessa si
comporti veramente secondo tali modelli.
Oltre alle esperienze descritte in questa sezione, i report di alcune attività di esplorazione condotte dalle classi delle scuole del 1° Circolo di Novi Ligure (AL) sono riportati a questo link:
IL CONCETTO DI MODELLO ALLE ELEMENTARI - I MARCHINGEGNI: Le macchine per pensare
Il tutor ha disegnato una specie di scatola avente a sinistra due caselle e delle frecce e a destra un’altra casella. Sulle caselle di sinistra ha scritto INPUT e su quella di destra OUTPUT. Nella scatola ha disegnato qualcosa di simile a un ingranaggio e scritto "MECCANISMO 1".
Inizialmente la maestra, di fronte alla lavagna, ha svolto la funzione di “scienziato” che proponeva i due numeri in input, mentre il tutor “faceva eseguire” il calcolo alla macchina operatrice disegnata alla lavagna e scriveva l’output, costituito da un singolo valore.
I bambini sono stati subito coinvolti in questo modo: “come il marchingegno, anche questa macchina ha al suo interno un meccanismo. Ancora una volta siete voi gli scienziati e dovete sforzarvi di pensare un modello delle operazioni che questa macchina compie. Ancora una volta avete solo un modo per valutare se il vostro modello funziona: effettuare altre prove, altri esperimenti, e verificare se le previsioni sono giuste.”
Dopo due tentativi proposti dai bambini e output scritti dalla macchina i bambini hanno subito compreso cosa dovevano fare e hanno iniziato a proporre delle ipotesi e chiesto se tali ipotesi fossero giuste. Il tutor ha ribattuto che la macchina non può rispondere direttamente alle domande, ma può solo essere usata per ripetere il calcolo su nuovi input, per produrre nuovi output che si confrontano con le nostre previsioni. Come non si poteva aprire marchingegno per vedere il suo contenuto, così non si poteva sapere cosa effettivamente faceva la macchina. Una volta capito il gioco, i bambini si sono proposti per fungere da macchine operatrici.
L’idea della macchine operatrici ha dato frutti. Dopo circa un mese i bambini, lasciati liberi dalla maestra, giocavano alle macchine operatrici: uno di loro alla lavagna fungeva da “meccanismo di calcolo” della macchina, con due input e due output, mentre gli altri bambini fornivano gli input e ipotizzavano modelli per i meccanismi (in figura un esempio).

Secondouna bambina questa macchina operava con il seguente modello: al primo numero si addiziona 7 per dare il primo output; il risultato si moltiplica per l’altro termine in input per dare il secondo output. Il modello scritto alla lavagna è stato cerchiato dal bambino che fungeva da “macchina operatrice” dopo due conferme sperimentali successive.
I bambini sono stati divisi in 5 gruppi, con il compito di trovare delle regolarità, delle relazioni come quelle delle macchine operatrici tra una variabile in input e una in output.
1. Tappi a corona, prima esperienza
Si dovevano realizzare degli schieramenti quadrati di tappi a corona. L’input era il numero di tappi del lato e l’output il numero di tappi totale del quadrato.

I bambini hanno individuato la relazione nascosta dopo pochi minuti e alla fine non contavano più i tappi, poiché sapevano già quanti ne servivano per completare i quadrati.
1. Tappi a corona, seconda esperienza
Il compito era lo stesso, solo che lo schieramento era a triangolo equilatero.

3. Cerchi
L’input era il diametro di oggetti rotondi, l’output era la circonferenza. Entrambe le variabili sono state misurate con un metro di stoffa precedentemente autocostruito dai bambini.

4. Molla
L’input era il numero di spire libere, l’output il numero di oscillazioni in 20 secondi. I bambini avevano a disposizione anche un cronometro.

5. Dado nella scatola
Una scatola conteneva un dado con facce di vari colori. Attraverso una finestra traslucida si poteva vedere solo una faccia del dado alla volta. In questo caso l’input era il numero di lanci e gli output erano i numeri di uscite di ciascun colore.
In questo caso si doveva ricostruire un modello concreto, anziché matematico, del dado.

Per i casi difficili (2,3,4) la regolarità cercata può essere un semplice grafico X-Y delle due variabili correlate. In effetti il grafico può essere usato per fare delle previsioni, come un qualsiasi modello.
Un'esperienza simile sulle regolarità nascoste è descritta in questa pagina.
Esperienze realizzate il 29-04 e il 27-05-2004 dai bambini della classe 4^ della scuola elementare di Appignano, con la maestra Daniela Governatori e il tutor Alfredo Tifi
In questa serie di esperienze sul concetto di modello e nelle indagini da esse stimolate è contenuto il nocciolo della scienza come impresa dell’intelletto. Questa percezione della scienza e la capacità di sentirsi protagonista di successo in tale impresa influenzerà certamente lo sviluppo cognitivo e affettivo del bambino più quanto non possa fare l’acquisizione di qualsivoglia nozione mnemonica e disciplinare sull’ambiente o sul corpo umano.
Il primo marchingegno
Il marchingegno che i bambini potevano vedere aveva un tappino e una penna infilati verticalmente a circa 5 cm di distanza su una scatolina di cartone.
Guarda il video
Inizialmente ai bambini è stato mostrato che ruotando il tappino anche la penna ruota, e lo fa nella stessa direzione. I bambini hanno affermato subito che c’è qualcosa che collega il tappino alla penna, dentro la scatola. Questo è quanto si richiede loro: “siete degli scienziati, fate le ipotesi e disegnate le ipotesi”.
E' stato utilizzato il seguente schema.

Le ipotesi disegnate sono chiamate modelli.
I modelli devono “funzionare” riproducendo il più possibile quanto accade nel sistema reale.
I bambini hanno ipotizzato vari meccanismi per il marchingegno e alcuni li hanno disegnati.
I modelli si mettono alla prova facendo esperimenti.
Perciò ai bambini è stato richiesto di proporre esperimenti.
1. I bambini hanno chiesto se il tappino si poteva togliere.
Il prof. ha verificato che si può togliere e rimettere il tappino senza problemi sul funzionamento.
I bambini hanno dedotto la presenza di un ingranaggio dove alloggiare il tappino che, infatti, presenta sei denti all’estremità infilata. Nei disegni sono apparsi ingranaggi.
2. È stato chiesto di invertire il verso di rotazione del tappino e vedere cosa accadeva.
Ruotando il tappo in senso antiorario, la penna non si metteva in rotazione. Un bambino è riuscito a spiegare tale asimmetria con un modello in cui un anello elastico, passante intorno al perno del tappino, va a toccare la penna solo da un lato, proseguendo poi verso un terzo perno rotante, interno alla scatola, disallineato rispetto agli altri due. In tal modo l’elastico si sarebbe allentato e non avrebbe fatto più presa sulla penna, ruotandolo in senso antiorario e mettendo in tensione il tratto che non è a contatto con l’asse della penna. Il bello è che il bambino era già al terzo modello disegnato in pochi minuti e che lui stesso ha spiegato alla classe il principio di funzionamento.
Diversi bambini chiedevano di aprire la scatola per vedere. Si è risposto loro che gli scienziati inventano dei modelli proprio perché non possono aprire i sistemi che studiano, ma possono solo fare esperimenti più o meno approfonditi su di essi.
Per esempio, come facciamo a sapere dove va il panino che ha mangiato un compagno? Non lo possiamo aprire! Siccome entra dalla bocca si potrebbe pensare che va nella testa. Ma se uno mangia troppo gli fanno male i piedi, la testa o la pancia? Il mal di pancia è un esperimento che conferma un modello in cui le cose che mangiamo vanno nella pancia. I bambini hanno detto che si può fare l’ecografia della pancia e vedere cosa c’è e che potremmo farla anche alla scatola. Ma a scuola non abbiamo la macchina per l’ecografia e gli scienziati avevano elaborato il modello secondo cui i panini vanno nella pancia anche prima dell’invenzione dell’ecografia.
Per sapere cosa c’è nel nucleo della Terra gli scienziati possono fare solo modelli e ipotesi. Si basano su ciò che si può osservare nella lava che esce dai vulcani e da esperimenti simili all’ecografia. L’ecografia della Terra si fa con delle esplosioni in certi punti della superficie. Le onde dell’esplosione si propagano e si registrano come delle piccolissime scosse di terremoto in altri punti molto lontani. Queste scosse non sono pericolose: solo le apparecchiature sensibili le registrano. Siccome le mini-onde di terremoto non vanno dritte, ma rimbalzano, gli scienziati capiscono che ci sono delle superfici in profondità che le riflettono, e in questo modo possono disegnare un modello dell’interno della Terra che somiglia a una pesca col nocciolo.

Nella classe 5ª abbiamo riproposto lo stesso “modello” di lezione, e i bambini hanno chiesto di effettuare più esperimenti e soprattutto hanno iniziato spontaneamente a costruire dei modelli concreti, oltre che disegnarli, usando penne, gomme, elastici, nastri di carta ecc.
|
|
Il “correttore”, a sinistra, è un esempio di “marchingegno” che può aver ispirato qualche bambino. |
Due gruppi hanno proposto, indipendentemente l’uno dall’altro, che nella scatola ci fosse qualcosa di similGuarda il videoe a una cassetta audio e ne hanno richiesta una alla maestra per fare le prove in simulazione.
Questo è un altro modo usato dagli scienziati per mettere alla prova i modelli: facendo esperimenti su sistemi artificiali anziché sui sistemi reali o naturali. Per esempio, per vedere quali alimenti preferiscono i pesci possiamo metterli in un acquario e fornire tali alimenti, anziché buttare i mangimi in acqua e correre dietro a ogni pesce per vedere quale mangia. Il difetto delle simulazioni è che non possiamo mai essere certi che nel sistema artificiale (acquario) succedano proprio le stesse cose del sistema naturale (mare). Per provare le medicine nuove si usano i topi: il loro organismo è usato come modello artificiale dell’organismo umano. Una medicina che fa bene al topo, però, non è detto che farà bene anche all’uomo.
I bambini di quinta hanno richiesto anche altri esperimenti e costruito i loro modelli (anche concretamente, come dei prototipi) sulla base dei risultati di tali esperimenti. Hanno pensato a soluzioni completamente originali: ingranaggi formati da ruote dentate con i denti solo su metà circonferenza e altri marchingegni con gomme forate ed elastici.
Gli esperimenti richiesti sono:
La classe ha concluso che il modello migliore è il meccanismo di un’audiocassetta e che se il sistema reale non contiene un’audiocassetta, deve somigliarle molto.
Ci sono altri esperimenti che si sarebbero potuti fare. Per esempio, se la penna viene fatta ruotare manualmente nella stessa direzione in cui era stata messa in moto dall’azione del tappino, questo rimane fermo. Se si ruota la penna dalla posizione iniziale questa risulta bloccata in senso antiorario mentre in senso orario non trasmette il moto al tappino. Dalla posizione iniziale solo il tappino è libero di ruotare in entrambe le direzioni, trascinando sempre la penna in senso orario.
Come applicazione del concetto di modello gli stessi gruppi di bambini hanno ricevuto un barattolo di caldo–caldo (cioccolato autoriscaldante) e una fotocopia dello spaccato vuoto entro il quale disegnare il “modello” di funzionamento del dispositivo di auto-riscaldamento. I bambini potevano anche vedere il cloruro di calcio e sentire il rumore derivante dal suo scuotimento, da un sacchetto di ricarica per deumidificatori. E' stata asportata dalle etichette dei barattoli la parte dove il “modello” era già disegnato. In questo caso è stato detto ai bambini che alla fine i loro modelli sarebbero stati verificati aprendo il barattolo col taglierino.

I bambini hanno ascoltato la provenienza del rumore del liquido (dal basso) e dei granelli di cloruro di calcio (dal centro). Un gruppo ha constatato la presenza di acqua sul fondo osservando controluce. Dopo aver disegnato la disposizione dell’acqua, della bevanda e del cloruro di calcio e stabilito la presenza di intercapedini e membrane da forare, hanno seguito le istruzioni per riscaldare il cioccolato e infine hanno assaggiato il prodotto.
altri marchingegni
Il marchingegno 1 è composto da un tappino e una penna.
Guarda il video
I bambini hanno notato che i due perni sono molto più vicini e hanno chiesto di ruotare il tappino: la penna ruota in senso contrario. Hanno poi chiesto di ruotarlo in senso opposto: la penna si mette subito in rotazione, ancora una volta nel verso contrario a quello del tappino. I bambini hanno concluso che i due perni ruotano sempre in direzioni opposte.
Un bambino ha proposto di agire sul perno alto. Ruotandolo, in ambedue le direzioni, il tappino si mette ugualmente in rotazione in senso opposto e in nessun caso “gira a vuoto”. I bambini hanno iniziato a ipotizzare la presenza di un elastico che avvolge due rotelle, interne alla scatola, in cui sono infilati i due perni. Hanno disegnato alla lavagna tale modello e sono stati invitati dal tutor a simularne il funzionamento, per verificarne la validità. Il tutor, per aiutarli, ha disegnato delle frecce lungo l’elastico (Modello a).
modello a
modello b
modello c
modello d
I bambini hanno notato che tale modello a prevede un moto concorde dei due perni, cosa che si scontra con i risultati sperimentali. Un bambino ha trovato subito la correzione appropriata al modello, disponendo l’elastico a “8” (Modello b). In effetti questo modello fornisce previsioni più vicine al comportamento reale.
Ma i bambini erano ormai abituati e non hanno concluso frettolosamente che tale modello coincidesse con la realtà. Infatti un altro bambino ha proposto un modello con due ruote dentate (Modello d).
Il tutor ha quindi proposto un altro esperimento, segnando col bianchetto un punto sul tappino, rivolto verso di loro. I bambini hanno notato che con un giro completo del tappino la matita fissata all’asta lunga compiva solo mezzo giro. Viceversa, un giro completo della penna causava due rotazioni del tappino. Dopo una breve discussione i bambini hanno modificato il modello introducendo una ruota più grande e una più piccola e, riflettendo sul meccanismo di trasmissione della bicicletta, hanno dedotto che la ruota più grande si deve trovare in corrispondenza della penna (Modello c).
Il tutor ha poi proposto il marchingegno 2, con due cannucce infilate come sempre parallele l’una all’altra, con l’estremità ricurva, come due L rovesciate, una gialla l’altra rossa.
Guarda il video
Dopo poche prove i bambini hanno notato che le parti alte delle due L rovesciate puntavano sempre nella stessa direzione anche dopo diversi giri, senza nessuno sfasamento. Immediatamente alcuni bambini si sono ricordati del Modello a del marchingegno precedente, che era perfettamente valido (cinghia elastica disposta ad anello su due rotelle di uguali dimensioni).
Questo è un esempio di come anche i modelli imperfetti non vadano mai “buttati”, poiché potrebbero tornare utili in altre situazioni.
Esperienze condotte l'11 e il 27-05 dai bambini delle classi 4^ e 5^ della scuola elementare di Appignano, con le maestre Verena Temperini e Daniela Governatori e dal tutor Alfredo Tifi
E' stato studiato un marchingegno così composto:

![]() |
![]() |
Per comprenderne il funzionamento e la struttura interna sono stati svolti i seguenti esperimenti:
Fase ideativa o sperimentale
Nei gruppi si è avviata una vivace discussione in cui si sono scambiate le idee e condivise le ipotesi. Quando si è raggiunto un accordo di massima, sono stati disegnati e illustrati i modelli che potessero funzionare come il marchingegno.
CONDIVISIONE DELLE ESPERIENZE
Ogni gruppo ha illustrato il modello prodotto, spiegandone il funzionamento.
![]() |
![]() |
| La calamita gira e fa girare l’altra calamita. Il giro, però, sarebbe lento e a scatti. | All’interno della scatola c’è un piccolo ingranaggio simile a quello della bicicletta con una catena che si incrocia ma non si tocca. |
![]() |
![]() |
| Ingranaggi presi da una cassetta musicale e da una vecchia cassetta per telecamera che è un po’ più grande con un elastico a forma di otto. | Sono stati usati quattro blocchi triangolari per costruire due ingranaggi a forma di stella. Al centro di ogni stella c’è un foro per inserire il tappo o la penna. Quando una stella gira, le punte toccano l’altra stella e la fanno girare in senso inverso.[1] |
![]() |
![]() |
| Nella scatola ci sono 3 perni su cui gira uno spago. Nei due perni laterali si infilano la penna e il tappo, mentre quello centrale serve a far cambiare direzione al filo. Il limite di questo modello è che lo spago finisce e la macchina non gira più nello stesso verso. | I due ingranaggi interni assomigliano a quelli di un orologio. |
Fase conclusiva
Tutti i modelli avrebbero potuto funzionare, ma il più semplice era il n° 6, che usava gli ingranaggi di un correttore.
E' stato studiato un marchingegno così composto:

Per comprenderne il funzionamento e la struttura interna sono stati svolti i seguenti esperimenti:
MODELLI PRODOTTI
![]() |
Due rulli ruotanti della stessa dimensione e fissati al centro con un perno sono collegati da un elastico che li fa girare nella stessa direzione. |
![]() |
Si usano tre rotelline dentate della stessa misura e fissate al centro con un perno. Se la prima ruota gira in senso orario, la seconda gira in senso antiorario e la terza in senso orario. In questo modo le due ruote esterne, dove si infilano le cannucce, girano sempre nello stesso verso. La rotellina centrale ha la funzione di far cambiare direzione al giro. |
Esperienze condotte il 30-04 dai bambini della classe 4^ della scuola elementare di Appignano, con la maestra Daniela Governatori e il tutor Alfredo Tifi
L'obiettivo era scoprire la relazione tra il numero di tappi del lato e il numero dei tappi che occorrono per costruire un quadrato.
| N. TAPPI LATO | N. TOT. TAPPI | ESEMPIO |
| 3 | 9 | ![]() |
| 5 | 25 | |
| 7 | 49 | |
| 8 | 64 | |
| 9 | 81 | |
| 10 | 100 | |
| 11 | 121 | CONCLUSIONE
Abbiamo scoperto che per trovare il n. totale di tappi basta moltiplicare il lato per se stesso (l 2) |
| 12 | 144 | |
| 13 | 169 | |
| 14 | 196 | Gruppo costituito da:
Valeria, Vanessa, Cristiana, Massimiliano |
L'obiettivo era formare con i tappi tanti triangoli, per capire la relazione che c’era tra il numero di tappi della base e il numero totale dei tappi che servono per costruire il triangolo.
| N. TAPPI BASE | N. TOT. TAPPI |
| 10 | 55 |
| 13 | 91 |
| 14 | 105 |
| 5 | 15 |
| 6 | 21 |
| 2 | 3 |
| 3 | 6 |
| 4 | 10 |
Un bambino ha notato che aggiungendo al numero di base un numero ogni volta inferiore fino a uno, si ottiene il numero totale dei tappi.

|
Questa regola, però, si può applicare solo a numeri piccoli, quindi bisognerebbe trovarne un’altra che si possa applicare anche a numeri più grandi. Una bambina ha scoperto che sommando al numero della base il totale del triangolo precedente si ottiene il numero di tappi occorrenti. Anche questa regola presenta un limite: è ricorsiva e occorre scrivere in ordine tutti i numeri altrimenti non funziona. |
![]() |
| N. BASE | N. TOT |
| 9 | 45 |
| 8 | 36 |
| 11 | 66 |
| 2 | 3 |
| 10 | 55 |
| 12 | 78 |
| 15 | 120 |
A partire da un'osservazione della maestra (combinazione 9 -> 45 = 9 x 10 :2) e seguendo l'intuizione di un bambino, la classe ha scoperto che moltiplicando il numero di base per un numero superiore di una unità e dividendo il risultato per 2 si ottiene il numero dei tappi necessari.

È stato difficile scoprire questa regola, ma essa si può applicare a tutti i numeri.
Nota: Il lavoro è stato iniziato da: Enrico, Dalila, Marianna, Mauro e completato da tutta la classe.
L'obiettivo era scoprire di che colore erano le facce di un cubo nascosto nel barattolo.
Dai lanci già effettuati sono usciti i seguenti colori:
I bambini hanno effettuato altri lanci per capire meglio com’era il modello del cubo. Le uscite sono state:
Sulla base delle uscite la maggior parte degli alunni ha correttamente disegnato tre facce bianche, due rosse e una gialla

Nota: Lavoro avviato da Martina, Mirko, Gioele, Nico e completato da tutta la classe.
L'obiettivo era contare il numero delle oscillazioni compiute dalla molla in dieci secondi, cambiando il numero delle spire, per scoprirne la relazione.
| COSTANTE: TEMPO (10 sec) | |
| N. SPIRE | N: OSCILLAZIONI |
| 5 | 17 |
| 7 | 16 |
| 10 | 14 |
| 15 | 11 |
| 20 | 9 |
| 25 | 8 |
| 30 | 7 |
| 35 | 6 |
| 40 | 5 |
I bambini hanno osservato che più spire si aggiungevano e più le oscillazioni diventavano lente e quindi il loro numero diminuiva.
Aiutandosi con la tabella hanno fatto una previsione approssimativa. Per esempio hanno dedotto che con 12 spire si potevano ottenere 12 o 13 oscillazioni e lo hanno verificato trovando che la previsione era esatta (12 oscillazioni).
Nota: Lavoro avviato da Riccardo, Maria, Jacopo, Maria Chiara e completato da tutta la classe.
Nota dell'insegnante: In questo caso trovare una relazione matematica tra numero di spire e numero di oscillazioni è un compito impossibile per i bambini. Il modello che consente di fare previsioni può comunque essere una semplice tabella o un grafico in un diagramma cartesiano. Dai dati della tabella dei dati sperimentali si ottiene il seguente grafico.

L'obiettivo era misurare la circonferenza e il diametro di vari oggetti circolari per capirne la relazione. La misura è stata effettuata con una fettuccia di cotone su cui erano tracciate a penna le linee dei centimetri e dei mezzi centimetri.
| CIRCONFERENZA | DIAMETRO | |
| BOTTIGLIA | 24 | 7 |
| MISURINO | 23 | 6,5 |
| ROTOLO NASTRO ADESIVO | 32 | 10 |
| BARATTOLO DECOUPAGE | 22 | 6 |
| B. VERNICE | 34,5 | 11 |
Dall’osservazione della tabella i bambini hanno fatto le seguenti riflessioni:
Quindi i bambini hanno diviso ciascuna circonferenza per il proprio diametro per scoprire se esiste un rapporto costante.
Nota del tutor: In questo caso sarebbe stato semplice fare una previsione, trovando un oggetto rotondo più grande degli altri, e verificare tale previsione, cosa che non è stata possibile per mancanza di tempo.
Questi i risultati:
24 : 7 = 3,48
23 : 6,5 = 3,53
32 : 10 = 3,2
22 : 6 = 3,66
34,5 : 11 = 3,14
Nota del tutor: La cifra dei centesimi non è significativa in questi calcoli; i dati andrebbero arrotondati al decimo.
I bambini hanno osservato che il numero intero di ogni risultato è sempre 3: il rapporto tra circonferenza e diametro è 3 virgola qualcosa. La maestra ha spiegato che i matematici facendo tante, tantissime operazioni di questo genere e calcolando la media aritmetica hanno scoperto che questo rapporto è 3,14.
Nota: Lavoro avviato da Nicola, Carlotta, Simone, Giulia e completato da tutta la classe.
Esperienza realizzata il 27-05-2004 dai bambini della classe 4° della scuola di Appignano, con la maestra Daniela Governatori
I bambini-scienziati della classe hanno osservato l'esistenza di molte muffe diverse, trasportate forse dalle cose che hanno appoggiato sulle piastre di "gelatina" incontaminata.
Questi i risultati:

Capelli (Federico e Riccardo) - Funghetti appassiti secchi (Asmba e Mattia) - Pane (Simone e Mattia)
Polvere (Martina e Leonardo) - Unghie varie (Matteo e Davide) - Sopracciglia (Matteo B. e Federica)
Le piastre contengono una gelatina nutriente (tecnicamente “terreno Sabourod agarizzato”) adatta alla crescita di tutte le muffe. Finché le piastre restano chiuse non si sviluppa in esse nessuna muffa né altro, così come dalla terra non cresce nulla se non si mette un seme o se un seme non si trova lì per caso. Quindi occorre mettere dentro qualcosa che possa contenere piccole spore, come quelle che si trovano sotto il cappello dei funghi.
Per questa esperienza basta aprire la piastra per il breve tempo sufficiente a inserire l’oggetto, richiuderla e lasciarla per qualche giorno in un luogo buio. Ogni cosa ha prodotto delle muffe, perciò si capisce che le muffe stanno un po’ dappertutto.
Constatata la crescita di una gran varietà di muffe, gli allievi hanno notato che ogni cosa aveva prodotto una muffa differente per aspetto, forma, colori. Perciò si sono chiesti se potesse esserci una relazione tra il tipo di muffa e l’oggetto che l’ha generata, cioè se ciascun oggetto fosse “contaminato” con un tipo preciso di muffa, oppure se la muffa si formasse casualmente.
Per rispondere a questa domanda ogni oggetto (per esempio la mollica di pane) è stato diviso e posto su due piastre uguali. Qui sotto i risultati.

Due metà di uno stesso spicchio di mela: le due muffe differiscono solo per l’estensione della zona grigia vellutata.

Due metà di uno stesso spicchio di mandarino: anche in questo caso si hanno le stesse colorazioni, ma con uno sviluppo molto diverso della peluria bianca.

Anche per la buccia di mandarino si ha una sostanziale corrispondenza nelle due piastre.
Si può concludere che le muffe sono nelle cose scelte per gli esperimenti.
Mentre si svolgeva l'esperimento gli allievi si sono accorti che nei barattoli delle pesche sciroppate che avevano mangiato c'era della muffa che galleggiava sul liquido. La maestra ha chiesto cosa fosse cambiato dal momento che avevano preparato le pesche a quello successivo all'aver aperto e richiuso il barattolo.
I bambini hanno risposto che era entrata l'aria e che le muffe potevano stare anche nell'aria. Allora i bambini hanno " raccolto" l'aria della classe per 5 minuti su una piastra e per altrettanti quella del giardino. E' risultato che l’aria del giardino contiene tanti tipi di muffe diverse, mentre l’aria della classe ne ha prodotto solo uno.
Questa ricerca sperimentale sulle muffe, che lascia aperte ancora varie domande, è stata utile alla nostra ricerca sulla conservazione degli alimenti, della quale si riporta una mappa concettuale.

Esperienza realizzata nel novembre 2004 dagli allievi della classe 4ªB del plesso Le Grazie, 2° Circolo di Recanati.
Il Materiale
La maestra ha portato a scuola questi materiali e oggetti:
L'Esperienza
I bambini hanno formato quattro gruppi. Ogni gruppo aveva un vassoio di alluminio con dei bicchieri di plastica trasparenti vuoti ed altri di plastica bianca. I bambini hanno abbinato i materiali a coppie, usandone solo una parte ogni volta.
Dovevano scoprire più cambiamenti possibili.
In ogni gruppo è stato scelto un responsabile della registrazione dei dati.
I bambini avevano a disposizione anche un secchio con acqua pulita e uno vuoto per scaricare i risultati delle prove e sciacquare i contenitori.
La maestra e il tutor hanno costruito alla lavagna una tabella a doppia entrata con i 5 materiali in riga e in colonna nello stesso ordine; hanno poi numerato le caselle corrispondenti a ogni diverso abbinamento da 1 a 10.

Legenda: G=guscio; A=aceto; R=radicchio; F=lana di ferro; B=bicarbonato
Infine sono state registrati le osservazioni e i cambiamenti ottenuti:
I bambini hanno osservato che si sono verificati casi in cui c’è stata azione tra l’uno e l’altro materiale. C’è stata quindi una interazione cioè una azione tra due cose, oggetti o materiali.
Hanno osservato anche che ci sono stati casi di non interazione (non si sono verificati cambiamenti rilevanti).
Dopo aver capito il concetto di interazione il tutor ha fatto altri esempi, chiedendo ogni volta se c’era interazione e perché.
Gli Esempi
Non c’era stata nessuna interazione tra i due materiali, ma c’era stata interazione tra calamita e ferro.
Il temperino ha trasformato la matita, la matita non ha cambiato il temperino; ma il temperino dopo tanto uso si consuma, quindi ci sarà interazione.
Ci sono tanti altri esempi di interazione: forbici-carta, gesso-lavagna, termosifone-aria, cibo-corpo, sega-legno, coltello-carne…
Il diario di bordo: i disegni dei bambini





Altre interazioni proposte dai bambini
Esperienza realizzata dai bambini della classe 3° della scuola elementare Castelnuovo (Recanati), con l'insegnante Maria Teresa Piattoni e il tutor Alfredo Tifi
L’aria e i polmoni, il fiato e il BTB, la lampadina, il filo e la pila, sono tutti esempi di sistema. Qualsiasi cosa che può interagire con un’altra forma un sistema. I bambini channo detto che sono sistemi anche il gessetto e la lavagna, il temperino e la matita, ecc. Non deve esserci per forza un’interazione, gli scienziati chiamano sistema un’unione di oggetti tra i quali si pensa ci possa essere una qualsiasi relazione o influenza reciproca.
Per queste esperienze i bambini sono stati divisi in gruppi di tre e ogni gruppo ha ricevuto i componenti di un sistema:
il tutto su un piatto grande di plastica.
Interazione Bicarbonato-aceto
L'obiettivo è vedere cosa accade in un sistema formato da aceto, bicarbonato e due bicchieri trasparenti su un piattino.
I bambini hanno proposto di versare l’aceto sul bicarbonato. Il risultato è che si forma una bella schiuma, come quando si versa la birra, che sale fino a uscire dal bicchiere. Qualche bambino ha detto che il liquido giallino che rimane con le bollicine sembra spumante, anche per l’odore.
Quindi il tutor ha spiegato ai bambini che i sistemi possono essere chiusi o aperti, a seconda se il materiale può liberamente entrare e uscire oppure no. Poi ha chiesto se quello appena visto era un sistema aperto o chiuso e i bambini hanno risposto, a ragione, che era aperto.
Il tutor ha poi chiesto se la bottiglia chiusa dell’aceto fosse un sistema aperto o chiuso, e i bambini hanno risposto che è chiuso, perché non può entrare né uscire nulla. La bottiglia aperta è stata invece definita un sistema aperto, perché esce l'odore. La risposta è corretta, poiché anche l’odore è fatto di materiale! Inoltre anche l’aria può entrare e interagire con l'aceto, e per questo si rovina se rimane aperto a lungo.
Ora l'obiettivo era far avvenire l'interazione tra bicarbonato e aceto in un sistema chiuso.
I bambini dicono che utilizzeranno il sacchetto, e aiutati dal tutor lo chiudono strettamente, attorcigliandolo prima di legarlo con il laccio. Questa la discussione nel corso dell'esperienza:
Vediamo un po’, secondo voi se il sistema è chiuso, l’interazione potrà avvenire lo stesso come nel sistema aperto?
I bambini hanno risposto di sì.
Bravi, e dove andrà a finire tutto il gas delle bollicine?
I bambini hanno risposto: nel sacchetto!
Allora vediamo chi riuscirà a far scoppiare il sacchetto.
A questo punto alcuni bambini hanno chiesto: “Come facciamo a farli interagire se prima dobbiamo chiudere il sacchetto?” Il tutor ha risposto che potevano usare gli stessi bicchieri e il sacchetto per tenere separati l’aceto dal bicarbonato finché non l’avranno chiuso bene. Alcuni hanno messo il bicarbonato nel sacchetto, altri hanno versato l’aceto nel sacchetto ehanno lasciato il bicarbonato nel bicchiere, altri ancora hanno messo entrambi i bicchieri in piedi nel sacchetto. Quindi hanno sigillato il sacchetto togliendo più aria possibile e poi hanno mescolato i materiali provocando l’interazione nei loro sistemi chiusi. Fortunatamente nessun sacchetto è scoppiato, anche se due di essi si sono gonfiati tanto da da aprirsi lungo una saldatura e far uscire un po’ di aceto.


Una volta riempiti i sistemi di gas, i bambini hanno provato a vedere come interagivano con il BTB. Per farlo, un po’ di bicarbonato è stato messo in una bottiglia vuota, e mezzo bicchiere di aceto è stato versato nel palloncino sgonfio. Il palloncino è stato posizionato sul collo della bottiglia e, solo quando il sistema era chiuso, l'aceto è stato versato nella bottiglia.
Il palloncino si è gonfiato molto, come si può vedere nella sequenza di foto qui sotto.



Quindi i bambini hanno preso la siringa con la cannuccia con l’ovatta “blocca liquidi”, l'hanno applicata all’uscita del palloncino e hanno immesso il gas all’interno del BTB, che dopo un po’ è diventato giallo-verde.
Ma nel palloncino c'erano ancora molte gocce di aceto: dopo un po’ una di queste ha superato la barriera del cotone ed è finita nel bicchiere con il BTB, che ha cambiato colore istantaneamente, passando da quasi giallo a giallo oro.
Esperienza realizzata dai bambini della classe 3° della scuola Castelnuovo di Recanati, con il tutor Alfredo Tifi
Questo è un esperimento semplice e significativo sul concetto di variabile, realizzato da ragazzi di seconda media.
Nell’ambito di un progetto di studio sulla fisica dei suoni, l'insegnante ha guidato i suoi allievi alla costruzione di uno strumento in legno con sei corde di nylon, il suonometro.
Lo strumento è stato costruito per rispondere al seguente problema sperimentale: da cosa dipende l’altezza del suono prodotto dalle vibrazioni di una corda tesa?
Sono state considerate tre variabili indipendenti (tensione, spessore e lunghezza delle corde) e una variabile dipendente (l’altezza del suono prodotto quando si pizzicano tali corde).
Le corde sono state realizzate con fili da pesca di due sezioni diverse.
Come si vede dalla foto qui sotto, le prime due corde da sinistra differiscono per la diversa tensione (ottenuta applicando dei pesi che agiscono verticalmente sulla parte libera): quella più tesa produce un suono più acuto. La seconda e la terza hanno lo stesso peso e la stessa lunghezza, ma differiscono in spessore: quella più spessa produce un suono più grave. Le altre tre corde, di identica sezione e con lo stesso peso applicato, hanno lunghezza decrescente e producono suoni di altezza crescente.

Foto del”suonometro” durante la mostra del 6 maggio
Si conclude che l’altezza del suono (rivelatrice della frequenza di vibrazione) è correlata positivamente alla tensione delle corde e inversamente alla loro lunghezza e al loro spessore.

Diagramma per lo studio dei fattori che influenzano l’altezza del suono prodotto dalle corde del suonometro

La mappa concettuale di questa esperienza realizzata dagli allievi
La teoria delle oscillazioni prevede, per una corda fissata a due estremità, una frequenza di oscillazione fondamentale pari a
(espressa in hertz, cioè oscillazioni complete al secondo).
In questa formula L è la lunghezza della corda, r è la densità lineare, cioè la massa di una sua lunghezza unitaria (ci dice quanto è pesante la corda e a parità di materiale è proporzionale all’area della sezione) e T è la tensione della corda a riposo, pari al peso che la tiene tesa.
I risultati trovati rispecchiano la formula perché:
Innanzitutto occorrerebbe mettere un “ponticello" sottile in corrispondenza della piegatura delle corde (come in una chitarra).
Inoltre il suono diverrebbe più udibile costruendo una cassa di risonanza.
Si potrebbe quindi realizzare un ponticello mobile in modo che la lunghezza della corda possa variare con continuità.
Sarebbe eccezionale poter misurare le frequenze di vibrazione con un apparecchio accordatore digitale e le tensioni con una bilancia sensibile al grammo. Si potrebbe verificare così la formula.
Le tensioni dell’apparecchio erano piuttosto basse e le corde piuttosto lente: occorrono quindi pesi maggiori.
La formula può essere verificata anche così: una corda di metà lunghezza dovrebbe oscillare con la stessa altezza di una avente lunghezza doppia ma con una tensione quattro volte maggiore. In questo caso si deve considerare che una tensione quattro volte maggiore comporterà una lieve diminuzione della densità lineare rispetto alla corda corta, e quindi un’altezza leggermente maggiore (si avranno battimenti?).
Esperienza realizzata dall’insegnante Michela Rossetti e dagli allievi della 2ª C della scuola media di Appignano
I bambini avevano già sperimentato le interazioni del BTB con diversi liquidi:
In questa esperienza, invece, i bambini dovevano vedere se e come il BTB interagisce con due gas: l’aria che espiravano e l’aria normale.
Ogni coppia di bambini aveva una cannuccia, un ampio vassoio, due bicchieri trasparenti con un del BTB azzurro, un palloncino, una siringa senza ago né pistone per adattarvi il palloncino e gorgogliare nel bicchiere. Due pompe per gonfiare palloncini sono state messe a disposizione della classe.
La maestra e il tutor hanno posto alcune domande:
Come fate per provare se c’è interazione del respiro con il BTB?
I bambini hanno risposto che intendevano usare la cannuccia.
E come farete per l’aria normale?
I bambini hanno risposto che avrebbero usato i palloncini.
Il tutor e la maestra hanno indicato le pompe adatte a gonfiare i palloncini come strumento da utilizzare per introdurre l'aria nei palloncini.
Ognuno dei bicchieri a disposizione era destinato a un tipo di aria. Tuttavia, nonostante l'avvertimento e il fatto che ogni coppia aveva una sola cannuccia, praticamente tutti i bambini hanno voluto provare a soffiare nelle cannucce e gorgogliare nei bicchieri, cosicché il BTB di tutti i bicchieri è diventato giallo.
Una volta gonfiati i palloncini con l’aria della pompa, i bambini hanno chiuso l’estremità della siringa e poi l'hanno rilasciata immergendola nel liquido. Poiché il livello del liquido era basso, alcuni bambini non arrivavano a immergere la siringa e soffiavano l’aria sulla superficie in pochi secondi, anziché farla gorgogliare lentamente dentro il liquido, per cui era necessario gonfiare di nuovo il palloncino e immergere il tubo una seconda volta.
Tutti hanno mostrato segni di delusione: si aspettavano un’interazione anche con l’aria della pompa. Questa la discussione seguita al risultato dell'esperimento:
Siete degli scienziati o no? Allora perché non registrate quanto accaduto? Non potete obbligare l’aria normale a interagire col BTB se non “vuole” farlo. Perché vi aspettate che lo faccia?
I bambini hanno risposto che, siccome il respiro aveva interagito, avrebbe dovuto farlo anche l’aria normale.
Ma l’aria del respiro è uguale a quella normale?
No! hanno risposto in coro.
Allora per questo non è detto che siano ugualmente capaci di interagire.
Per dimostrare la differenza tra i due tipi di aria è stato effettuato un esperimento in “parallelo”, in cui sia l’aria normale, sia quella del respiro sono state usate per riempire due palloncini e quindi gorgogliate in due quantità uguali di BTB di identico colore. Il risultato, visibile dal filmato, conferma l’incapacità dell’aria normale di interagire col BTB.
Guarda il video dell'esperimento
Perché l’aria respirata è diversa da quella normale?
Alcuni bambini hanno risposto che è perché l’aria respirata viene dai polmoni.
Ma prima di entrare nei polmoni era normale o no?
I bambini hanno risposto di sì.
Dunque quando si modifica l’aria normale?
I bambini hanno risposto che si modifica quando sta nei polmoni.
E come fa? Cosa accade tra i polmoni e l’aria?
Alcuni bambini hanno detto che c’è interazione tra polmoni e aria.
Esperienza realizzata il 20-01-2005 dai bambini della classe 4ª della scuola Le Grazie di Recanati
I bambini avevano già provato che, soffiandovi con le cannucce, il BTB cambiava colore, mentre gorgogliando l’aria con le siringhe non accadeva nulla. I bambini hanno detto che l’aria respirata è diversa perché è “usata”. Se tutti respirano, l’aria dell’aula si modifica, perciò ogni tanto si apre la finestra per fare entrare l’aria non “usata”.
Il tutor e un bambino della classe sono usciti con due palloncini di gomma vuoti e una pompa. Quando sono rientrati i due palloncini erano pieni allo stesso modo, uno con aria normale e uno con l’aria espirata. Il tutor ha chiesto quale fosse quello gonfiato con il fiato?
Un bambino ha detto che il palloncino con l’aria espirata doveva cadere verso il basso e l’altro andare in alto. Questa è un ottima idea! L’aria usata deve pesare di più.
Per fare la prova i palloncini sono stati chiusi bene con dei laccetti leggeri e poi lasciati andare insieme. Entrambi sono caduti verso il basso, ma uno dei due arrivava sempre prima dell’altro, nonostante nel frattempo si fosse un po’ rimpicciolito. Quello era il palloncino gonfiato col fiato.
Nota del tutor: i bambini dovrebbero provare a invertire i palloncini, a gonfiarli esattamente allo stesso modo, per vedere se tale differenza di peso è sufficientemente elevata da rendere riproducibile la prova in ulteriori esperimenti, o se si è trattato solo di un caso.
Altri bambini hanno detto che si poteva riconoscere il palloncino con l’aria “usata” anche provando a mandarla nel BTB.
All’uscita di ogni palloncino è stata inserita una siringa di plastica senza pistone e la punta di questa è stata prolungata con la cannuccia del succo di frutta. Siccome un bambino sosteneva che fosse la saliva a causare sia il maggior peso sia il cambiamento di colore del BTB quando si soffiava nella cannuccia, il tutor ha inserito dei batuffoli di cotone ben pressato dentro le cannucce, impedendo così qualsiasi passaggio di piccole goccioline di liquido. I laccetti sono stati tolti e i bambini hanno iniziato a far gorgogliare le “due arie” in due bicchieri contenenti la stessa quantità di BTB blu.




Il gorgoglio avveniva lentamente, perché il cotone rallentava il passaggio dell’aria. Dopo un po’ il BTB del palloncino col fiato, quello che cadeva più in fretta, è diventato giallo, confermando che lì c’era aria espirata e anche che la saliva non poteva essere la causa del cambiamento di colore. Proseguendo con l’interazione, una bambina ha notato che anche nel bicchiere dell’aria normale sembrava esserci un piccolo cambiamento: il colore diventava più blu.
Alla fine l’aria normale abbiamo è stata fatta gorgogliare nel bicchiere con il BTB giallo-verde e si è visto che il colore tendeva a ridiventare azzurro! I bambini hanno ipotizzato che l’aria “usata” potrebbe contenere un gas che la rende più pesante e che interagisce col BTB; questo gas sarebbe scacciato in fretta gorgogliando l’aria normale. Anche lasciando semplicemente all’aria il BTB giallo-verde, questo gas potrebbe uscire da solo e, in tal caso, il BTB ritornerebbe blu da solo. Perciò abbiamo lasciato il bicchiere col BTB giallo nell’angolo della stanza, per osservarlo il giorno dopo.
Il tutor ha chiesto ai bambini come potesse l’aria normale cambiare e divenire capace di far diventare giallo il BTB. I bambini hanno risposto che ciò avviene nei polmoni. Ha chiesto quindi cosa può accadere tra aria e polmoni e i bambini hanno risposto correttamente che c’è un’interazione. Quindi il tutor ha fatto una prova, chiedendo ai bambino se secondo loro l’aria interagisce nello stesso modo se si fa un lungo respiro sospeso o se la si fa entrare e un attimo dopo la si fa uscire. I bambini hanno risposto che più tempo sta, più l’aria interagisce e si modifica.
E' stato quindi condotto un esperimento capace di verificare se l’aria che rimane più a lungo interagisce maggiormente nei polmoni. Una bambina (Carlotta) ha trattenuto il respiro per 30 secondi e poi ha espirato tutta l’aria, gonfiando il palloncino. Un’altra bambina (Sabrina), è stata chiamata a riempire un altro palloncino facendo piccoli soffi (facendo in modo, cioè, che ogni volta l’aria restasse solo un istante nei polmoni). Entrambi i palloncini sono stati gonfiati allo stesso volume e collegati, come prima, alle cannucce con il cotone. Mandando l’aria in due bicchieri di BTB blu uguali si notava che l’aria espirata da Carlotta dopo pochi secondi faceva diventare il BTB giallo, molto più giallo di quello che si otteneva soffiando con le cannucce. L’aria che aveva interagito poco con i polmoni, espirata da Sabrina, invece, riusciva a malapena a far diventare verde il liquido, anche quando il palloncino si era completamente sgonfiato.

Test del fiato trattenuto (a destra) e non trattenuto (a sinistra)
Alla fine dell'esperienza il tutor ha proposto questa situazione: "Immaginate un sub che ha finito l’aria delle bombole, ma ha un palloncino. L’ultimo respiro di aria buona potrebbe usarlo per riempire il palloncino, come ha fatto Carlotta, e poi riprendere l’aria da lì ogni volta che deve inspirare, rigonfiandolo ogni volta che espira, e andare avanti così finché non riesce a tornare in superficie. Ce la farebbe?” I bambini si sono messi a ridere e hanno detto che soffocherebbe, proprio come se si trattenesse di continuo la stessa aria nei polmoni, poiché respirandola questa si consumerebbe sempre di più.
Aceto e BTB
Con la punta di una cannuccia il tutor ha toccato l’aceto e poi il BTB del bicchiere, che diventa giallo oro, un colore molto più intenso del giallo ottenuto col fiato trattenuto (vedi sopra).
Acqua minerale e BTB
Ripetendo l'esperimento con l’acqua minerale, il BTB è diventato di un bell’azzurro brillante e intenso. Un bambino ha detto che il BTB è un camaleonte.
Un altro ha proposto di provare il bicarbonato con il BTB. Il risultato è stato un bellissimo colore blu china. Un altro bambino ha scoperto che nell’etichetta dell’acquaminerale usata per l'esperimento c’era scritto “bicarbonato” e che per questo essa faceva diventare blu scuro il BTB.
A questo punto il tutor ha fatto notare che quando per sciogliere il BTB in polvere era stata usata dell'acqua minerale che contiene bicarbonato, main quel caso la soluzione diventava azzurra e non blu scura. Per la spiegazione è bastato leggere l’etichetta della bottiglia isata per la preparazione del BTB, in cui la quantità di bicarbonato presente è meno della metà di quella dell'acqua usata per l'esperimento.
Per concludere l'esperienza il tutor e i bambini hanno ricostruito uno schema di tutti i colori e le interazioni del BTB.
Esperienza realizzata dai bambini della classe 3° della scuola Castelnuovo di Recanati, con il tutor Alfredo Tifi
Un'esperienza simile è descritta in questa pagina.
I bambini avevano a disposizione una bottiglia di acqua minerale e del BTB in polvere che è stato versato nell'acqua e fatto sciogliere.
Ai bambini è stato consegnato un bicchiere contenente BTB e una cannuccia e sono stati invitati a soffiare nel bicchiere e ad osservare ciò che avveniva.
Questi i commenti.
Poi Apollonia ha gonfiato un palloncino con il proprio fiato, mentre Gaetano ha usato una piccola pompa per gonfiarne un altro e ha proposto di mischiare anche l'aria del pallone gonfiato con l'aria esterna.

I bambini hanno fatto gorgogliare l'acqua nei due bicchieri contenenti BTB giallo.

Un bambino ha affermato che l'aria esterna è più inquinata perchè ci sono lo smog e il fumo.
Per provarlo, qualcuno ha avanzato l'idea di far entrare "l'aria piena di fumo" nel bicchiere per farla interagire con il BTB.
Per farlo, i bambini hanno arrotolato un foglio di carta, lo hanno acceso e quando ha cominciato a "fare fumo", un bambino lo ha posizionato al centro del bicchiere coprendolo con le mani.
Il BTB ha cambiato colore, diventando di un blu brillante.

Ora i bambini avevano tre bicchieri con il BTB di tre colori diversi.
Il BTB giallo è stato versato in un contenitore di plastica trasparente, che viene messo sull'armadietto insieme ai bicchieri contenenti il BTB verde e il BTB blu.
Le immagini dell'esperienza

Esperienza realizzata il 10-02-2005 dai bambini della classe 4° B della scuola elementare di via dell'Aia di Scanzano Jonico, con la maestra Maria Rosaria Filippelli e il tutor Antonietta Lombardi
Un'esperienza simile è descritta in questa pagina.
Qualche volta succede che qualcosa ci colpisce, ci incuriosisce, ci domandiamo come potrebbe funzionare e magari ce lo immaginiamo e quando non è possibile esplorare ciò che ci ha interessato possiamo pensare dei sistemi possibili di funzionamento. Se non funziona, il nostro modello va modificato.
Abbiamo osservato che la scatola aveva due buchi su due facce opposte, da uno usciva un filo bianco e dall’altro un filo nero ma la cosa strana era che tirando un filo l’altro veniva trascinato dentro e il primo non cambiava colore come ci si aspettava, continuava ad uscire tutto nero o tutto bianco.
Quali sono stati i nostri pensieri?
Potremmo dire che il rumore che si sentiva provenire dall’interno è stato un indizio utile per farci ricordare qualche nostra esperienza in cui quel rumore c’era o gli assomigliava. Per esempio ad Asmaa ha fatto pensare ai fusi che servono per filare la lana (che lei ha visto usare) a Silvia il rumore del rocchetto della macchina per cucire, ad altri , ingranaggi e rotelle. Vedere che il filo se lo tiravi da una parte trascinava con sé anche l’altro ci ha fatto capire che dovevano essere collegati e non potevano esserci due “aggeggi”. Federico aveva con sé (ha sempre tanti “aggeggi “ ) un rocchetto, abbiamo annodato due fili di colori diversi sul rocchetto e infilato una matita nel rocchetto. Tenendo ferma la matita , il rocchetto era libero di muoversi ed infatti il nostro modello funzionava. Tirando l’estremità rosa quella verde si arrotolava, srotolando quella verde si arrotolava quella rosa.

Guarda il video del modello prototipo del meccanismo della scatola bianca
Guarda il video della scatola bianca
La seconda scatola era rossa, il rumore che proveniva dal suo interno era minore dell’altra. Abbiamo visto che se tiravi tutti e due i fili la scatola , appoggiata sul tavolo, si muoveva solo dalla parte del filo rosso. Se tiravi il filo rosso il giallo entrava di più, invece se tiravi quello giallo il rosso entrava di meno.Infatti la cosa strana era che tirando il filo giallo di 30 cm. il filo rosso si accorciava di 17cm.. Abbiamo detto in classe come poteva accadere perché il professore ci aveva detto di immaginare il funzionamento così come hanno fatto gli scienziati con il Sole perché “…non ci si può andare”. Abbiamo capito che c’erano due rullini, ma come faceva? Abbiamo discusso molto e alla fine abbiamo capito che doveva esserci uno più grande e uno più piccolo , così abbiamo creato un modello. La maestra è andata a prendere un tubetto di colla, pensando di doverne cercare poi uno più piccolo ma Asmaa, intuendo quello che la maestra stava pensando, si è accorta che nel tubo del vinavil erano presenti già grandezze diverse. Abbiamo arrotolato, allora, i due fili, uno sul tappo e uno sul contenitore, ci abbiamo provato e dopo un po’ ci siamo riusciti; il mistero era ormai risolto.

Guarda il video della scatola rossa
In occasione della festa della mamma abbiamo realizzato queste scatole magiche per fare gli auguri e… sorprendere! Riusciranno le nostre mamme a capire cosa c’è dentro?

Esperienza realizzata il 28 aprile 2005, dai bambini della classe 4° B della scuola Le Grazie di Recanati con l'insegnante Pina Feliciotti e il tutor Alfredo Tifi
I problemi che i bambini hanno dovuto affrontare, lavorando a piccoli gruppi, consistevano nel dover separare un sistema di aghetti e lenticchie e un sistema di aghetti, lenticchie e sale, entrambi mescolati all’interno di un barattolino.
I sei gruppi avevano a disposizione un barattolino col fondo pieno di buchi, ma non sapevano a cosa servisse.

Alcuni bambini hanno iniziato a separare gli aghetti dalle lenticchie manualmente, ma in tutti i casi si sono poi resi conto che l’operazione poteva essere molto più rapida e divertente usando il barattolino con i buchi, dai quali potevano passare solo gli aghetti. Non in tutti i casi i bambini hanno pensato di chiudere il barattolino mentre lo agitavano, per cui alcune lenticchie uscivano e venivano singolarmente recuperate a mano. Alla fine tutti avevano il sottosistema lenticchie nel barattolo e il sottosistema aghetti nel piattino.
Discussione
Qual è la principale differenza tra i due sottosistemi?
Gli aghetti sono piccolini e fini
Perché si sono separati gli aghetti dalle lenticchie?
Perché sono piccoli e passavano dai buchi
Perché le lenticchie non passano attraverso i buchi?
Perché sono grandi
Quale proprietà può essere “grande” e “piccola”?
Nessuna risposta
Giallo verde e marrone cosa sono?
Colori
Allora la proprietà del giallo e marrone è il colore. E qual è la proprietà del grande e piccolo?
Dimensione

Agli stessi gruppi è stato consegnato un nuovo barattolino contenente, stavolta anche il sale fino in aggiunta a lenticchie e aghetti, con il compito di separare i due sottosistemi di prima. Essi disponevano anche di acqua. Alcuni bambini hanno detto che usando lo stesso metodo di prima sarebbe passato anche il sale. Quindi abbiamo detto loro che serviva un metodo per separare il sale dalla pastina. A cosa può servire l’acqua? Un bambino ha chiesto se la pastina si scioglie con l’acqua e gli altri bambini hanno risposto di no, mentre il sale sì. Quindi, prima di operare i bambini hanno stabilito le tappe: 1. separare le lenticchie dagli altri due sottosistemi; 2. aggiungere acqua per sciogliere il sale e poi scolare l’acqua salata, lasciando gli aghetti nel piatto.
I bambini hanno operato come stabilito e notato che il sale si scioglieva del tutto, ma che l’acqua salata e scolata nei bicchieri non era perfettamente limpida: c’era una polverina. Inoltre gli aghetti bagnati si attaccavano tutti uno all’altro.


Discussione
Che succedeva se mettevate l’acqua subito nel bicchieretto?
Si bagnavano anche le lenticchie; gli aghetti si compattavano e non uscivano più facilmente dai buchi
Se uno volesse recuperare il sale a cristalli, come dovrebbe fare?
Facciamo evaporare l’acqua
E il sale non evapora?
No
Perché?
Perché l’acqua evapora e il sale no.
Avete mai visto il sale lasciato fermo in un barattolo aperto evaporare?
No
E l’acqua?
Sì
Ecco, allora avete ragione voi perché avete portato delle prove, non basta dire sì o no! Prima avete separato le lenticchie grazie alle diverse dimensioni. Ora come si chiama la proprietà che vi ha fatto dividere il sale dagli aghetti?
Che si scioglie.
Più o meno, sì. La capacità di sciogliersi è una proprietà con l’accento sulla a e si chiama solubilità. Conoscete qualche altro materiale che ha la solubilità in acqua?
Lo zucchero.
Avete mai visto lo zucchero a velo?
Sì
Che differenza c’è con quello normale?
È più fino
Con le dita si riesce a prendere un piccolo pezzetto singolo di zucchero normale?
Sì
E di quello a velo è possibile prendere un solo pezzetto senza usare la lente?
No! I pezzetti sono piccolissimi!
Esperienza realizzata il 28 aprile 2005 dalla classe 3ª A della scuola Castelnuovo (Recanati)